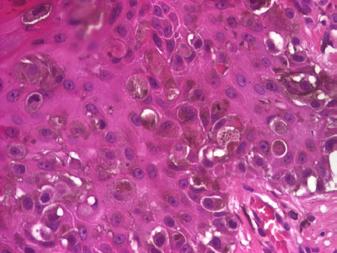

exigență în calitate
Prof. Univ.
Dr. Călin Giurcăneanu


Președinte al SRD

exigență în calitate
Prof. Univ.
Dr. Călin Giurcăneanu


Președinte al SRD


Dr. Alin Nicolescu
Secretar General al SRD
Revista profesioniștilor din Sănătate • 2023 - 2024

• Publicație creditată B+ conform



Prof. Univ.
Dr. Maria Rotaru
Clinica Dermatologie
Facultatea de Medicină, Universitatea „Lucian Blaga” Sibiu
Prof. Univ.
Dr. Alexandru Tătaru
UMF „Iuliu Haţieganu” Cluj Dept. Dermatologie
Prof. Univ.
Dr. Ioan Nedelcu


CMI Nedelcu Ioan, București
Ș.L. Dr. Florica Șandru
UMF „Carol Davila” Sp. Universitar de Urgență Elias
As. Univ. Dr. Farmacist Antonia Radu
UMF Craiova Dept. de Botanică Farmaceutică

Dr. Livia-Cristiana Băicoianu-Nițescu Medic rezident Dermatovenerologie, Sp. Universitar de Urgență Elias




250 ULS capsule moi 600 ULS/2 ml soluție injectabilă
Acest material promoţional este destinat profesioniştilor din domeniul sănătăţii. Pentru informaţii suplimentare vă rugăm să consultaţi rezumatul caracteristicilor produsului complet, disponibil la cerere sau pe site-ul www.anm.ro. Vessel Due F® 250 ULS capsule moi - o capsulă moale conţine sulodexid 250 ULS (unităţi lipasemice sulodexid). Administrare orală. Medicament eliberat pe bază de prescripţie medicală – P6L. Vessel Due F® 600 ULS/2ml soluţie injectabilă - 2 ml soluţie injectabilă conţin sulodexid 600 ULS (unităţi lipasemice sulodexid). Administrare im/iv. Medicament eliberat pe bază de prescripţie medicală – PRF. Profesioniștii din domeniul sănătăţii sunt rugaţi să raporteze orice reacţie adversă suspectată sau reclamaţie cu privire la acest produs la adresa de e-mail: Drugsafety.alfasigma@addenda.ro sau la Agenţia Naţională a Medicamentului și a Dispozitivelor Medicale din România, www.anm.ro. DAPP Alfasigma - S.p.A.

Alfasigma România S.R.L. str. Cluceru Udricani, nr. 18, parter și etaj 1, sector 3, București tel.: 031.805.35.26, 031.805.35.27; fax: 031.805.35.28. e-mail: info.ro@alfasigma.com







Importanța evaluării imunohistochimice în diagnosticul diferențial al unui caz paradoxal de melanom malign cutanat As.
60
Sindromul Muir Torre (varianta fenotipică a Sindromul Lynch cu manifestări cutanate)
Oana Cristina Voinea MD. PhD.
Sclerodermia juvenilă localizată (Morfeea) Dr. Iulia-Maria Gălămîj
64
70
Copierea fără acordul scris al editurii a oricăror elemente de grafică sau conținut editorial apărute în revistele editurii sunt considerate furt de proprietate intelectuală şi intră sub incidența legii.
Dr. Alexandra-Maria Roman
Medic rezident Dermatovenerologie, Sp. Univ. de Urgență Elias
Dr. Cherim Aifer
Medic rezident Dermatovenerologie, Sp. Univ. de Urgență Elias
Dr. Teresa Petre
Medic rezident Dermatologie, Sp. Univ. de Urgență Elias
Dr. Miruna Borjoc
Medic rezident Pneumologie Pediatrică, Spitalul Clinic de Urgență pentru Copii „Grigore Alexandrescu” București
As. Univ. Dr. Laura Elena Mocanu
CMI Nedelcu Ioan, București
Dr. Andreea-Maria Radu

Medic rezident Dermatovenerologie, Sp. Univ. de Urgență Elias
Dr. Adelina Popa
Medic rezident Dermatovenerologie, Sp. Univ. de Urgență Elias
Dr. Iulia-Maria Gălămîj

Medic rezident Pediatrie Spitalul Cinic de Urgență „Grigore Alexandrescu“ București
Consultant medical: Dr. Aurora Bulbuc, medic primar Medicină de familie





Editor Calea Rahovei, nr. 266-268, Sector 5, Bucureşti, Electromagnetica Business Park, Corp 01, et. 1, cam. 4 Tel: 021.321.61.23

e-mail: redactie@finwatch.ro ISSN


Expunerea excesivă la soare şi, mai grav, fără folosirea protecției solare, reprezintă o problemă majoră de risc în dezvoltarea cancerului de piele. Se estimează că, până în 2043, incidența cancerului de piele va creşte cu 85%. Vă rugăm să ne spuneți care este procentul pacienților cu melanom în România (dacă se cunoaşte), ce investigații trebuie făcute pentru stabilirea diagnosticului şi care sunt terapiile inovatoare pentru melanomul aflat în stadii avansate.
Melanomul este considerat cea mai gravă formă de cancer cutanat. Incidența sa a crescut semnificativ în întreaga lume în ultimele decade. În SUA, este a cincea formă de cancer ca frecvență la bărbați și a șasea la femei reprezentând aproximativ 5% dintre toate cancerele nou diagnosticate.
Ratele de mortalitate au crescut mult în ultimii ani, dar nu atât de mult precum cele de incidență.
Deși reprezintă 2-5% din toate cancerele cutanate, ratele de deces prin melanom reprezintă 80-90 % din cele prin cancer cutanat în general.
În România încă nu există date despre prevalența și incidența melanomului, totuși una dintre preocupările majore ale Societății Române de Dermatologie este legată de situația cancerelor cutanate –parte integrantă în Registrul Naționalașa cum ele, deja, au fost obținute pentru psoriazis și dermatita atopică.
În Australia melanomul reprezintă o mare problemă, estimându-se că unul din 70 de locuitori poate avea o formă de melanom. Dintre principalii factori de risc menționez:
• Expunerea excesivă la soare, solar etc;
• Îmbrăcămintea de culoare închisă;
• Arsuri solare în copilărie sau adolescență;
• Antecedente familiale de melanom, nevi atipici, boli genetice (xeroderma pigmentosum);
• Imunosupresii (pacienții transplantați);
• Piele deschisă la culoare, păr blond, ochi de culoare deschisă (fototip I și II, fenotip asociat cu risc crescut de melanom);
• Prezența unui număr mare de nevi melanocitari (>50); totuși, 70% din melanoame apar de novo (pe pielea aparent sănătoasă);
Diagnostic – clinic și cu mijloace ajutătoare
• Vizualizarea (eventual lupă) la lumină naturală pune diagnosticul cu o acuratețe de 70%; analiza vizuală a tipului de nevi ai pacientului și catalogarea lor conform criteriilor ABCDE (Asimetrie, Margini neregulate, variații de Culoare, Diametru, Evoluție);
• Prezența unui nev altfel decât ceilalți pune semne de întrebare (ex. „ugly duckling”);
• Analiza dinamică pentru a vedea evoluția și modificările produse în timp.
• Tehnici (mijloace) ajutătoare ale diagnosticului clinic:

▶ Dermoscopia (sau dermatoscopie), microscopia de epiluminiscență, microscopia de suprafață cutanată) – cea mai importantă – este o tehnică neinvazivă care se face cu un aparat numit dermatoscop pe care îl poate avea orice medic dermatovenerolog în cabinetul său; procedura vizualizează structuri cutanate invizibile ochiului liber; imaginile dermatoscopice pot fi fotografiate sau înregistrate digital pentru stocare sau monitorizare secvențială.
Alte tehnici:
• Microscopia de reflectanță confocală;
• Sisteme bazate pe dermoscopie digitală;
• Sisteme bazate pe imagini multispectrale (FotoFinder, SIAscope etc)
• Inteligența artificială (ex. aplicații smartphone)
Diagnostic de confirmare
• Biopsia incizională sau excizională (completă);
• Examen histopatologic care evidențiază rata mitotică, infiltratul inflamator peritumoral, indice Breslow, nivelul de invazie Clark;
• Imunohistochimie: markeri S100, HMB45 etc.
• Tehnici moleculare
Terapii inovatoare
Înainte de toate, precizez faptul că succesul terapeutic depinde foarte mult de un diagnostic cât mai precoce, urmat de investigații de extensie și tratament inițiat cât mai rapid.
Pacienții cu melanom metastatic vor fi evaluați foarte atent pentru a aprecia extensia bolii – confirmare patologică a bolii metastatice, tehnici de imagistică (CT torace, abdomen, pelvis; PET – CT; RMN cerebral), LDH seric (LacticoDeHidrogenaza), dar și mutația BRAFV600.
Terapiile care se pot administra după această evaluare ar putea fi:
a. Terapii țintite
• Asociere de inhibitori BRAF cu inhibi-
tori MEK (calea proteinkinazei mitogen activate) ex. Dabrafenib asociat cu Trametinib sau Vemurafenib + Cobimetinib; această terapie este eficientă la 50 % din cei cu melanom, respectiv cei ce au mutația BRAFV600.
• Terapie de iradiere ex. radiochirurgia stereotactică la cei cu metastaze cerebrale.
b. Imunoterapie de inhibiție a punctului de control – cum ar fi asocierile de Nivolumab cu Ipilimumab sau Nivolumab cu Relatlimab, toate aceste terapii apărând în urma unor studii și cercetări aprofundate. Așa s-au dezvoltat inhibitorii PD-1 (Programmed Cell Death 1 ex. Pembrolizumab, Nivolumab), inhibitorii
CTLA-4 (citotoxyc T lymphocyte Associated Protein Form ex. impilimumab) și inhibitorii LAG3 (ex. Relatlimab).
Psoriazisul este mai mult decât o afecțiune dermatologică. Dincolo de afectarea pielii, psoriazisul are răsunet asupra întregului organism. Care sunt terapiile dezvoltate în ultimul an conform Ghidului actualizat? Sunt acestea decontate de CAS? Este nevoie de o echipă multidisciplinară în abordarea pacientului cu psoriazis?
Este considerat că psoriazisul este o boală mai mult decât dermatologică, așa încât, din start, menționez faptul că el are un mare impact asupra întregului organism al pacientului. Ca atare este necesară o echipă multidisciplinară pentru un management eficient și persoanlizat fiecărui pacient, echipă în centrul căreia trebuie să se afle medicul dermatolog.
Deși datele de prevalență pe plan mondial sunt de circa 2%, incidența sa a crescut în anii 2000 de circa 2-2.5 ori față de anii 1970. Ne mândrim cu faptul că, sub egida Societății Române de Dermatologie, a fost efectuat un studiu de prevalență în psoriazis care arată valori mai mari decât cele pe plan mondial, adică 4,9, din care un sfert au și afectare articulară.
De fapt este o afecțiune inflamatorie cronică, multisistemică, cu punct de plecare cutanat, în care factorii genetici (care produc proliferări necontrolate epidermice sau importante atingeri ale sistemului imunitar înnăscut și adaptativ) se întrepătrund cu factori de mediu: stres, fumat, consum de alcool, obezitate, medicamente, infecții, deficit de vitamina D.
Așadar, pacientul cu psoriazis poate prezenta o serie de manifestări extracuta-
nante, motiv pentru care este nevoie de acea echipă multidisciplinară. Dintre aceste manifestări menționez: artrita psoriatrică, obezitate, sindrom metabolic, boală cardiovasculară, cerebrovasculară și vasculară periferică, boli autoimune, boală cronică renală, boală hepatică nealcoolică, boală pulmonară obstructivă cronică, apnee în somn, boli inflamatorii cronice intestinale, inflamație oculară, parkinsonism, efecte psihosociale, boli psihiatrice, abuz de alcool etc.
Iată de ce alegerea unei terapii personalizate, predictive pentru fiecare pacient reprezintă o provocare, o mare responsabilitate și în ultimă instanță, o adevărată artă.
Depășind nivelul terapiilor topice, al terapiei cu ultraviolete A sau B cu bandă îngustă (311 nm), intrăm în domeniul terapiilor convenționale sistemice (Methotrexat, retinoizi aromatici, cyclosporina A, acid fumaric) și dacă acestea nu dau rezultate putem încerca terapii inovstoare cum ar fi cele biologice sau moleculare.
În România cele mai multe dintre acestea sunt decontate de CAS.
Între terapiile moleculare amintesc de apremilast (inhibitor de fosfodiesterază 4), iar dintre agenții biologici amintesc de cei anti-TNFalfa (factor de necroză tumorală alfa): etancercept, infliximab, adalimumab, certolizumab pegol, anti IL12/IL-23 (ustekinumab), anti IL-17A sau receptor IL-17 A (secokinumab, ixekizumab, brodalumab) și anti IL-23 (tildrakizumab, guselkumab, risankizumab).
Menționez că multe din aceste terapii au și biosimilare cu o eficiență foarte bună. Procentul românilor cu dermatită atopică a crescut în ultimii ani, această afecțiune manifestându-se încă de la naştere. Care sunt cauzele?
Dermatita atopică este o boală cutanată cronică intens pruriginoasă, care afectează mai frecvent copiii, dar și adulții.
Se observă în ultimele decade o creștere semnificativă a incidenței și prevalenței eczemei atopice în Africa, Asia sud-est, vestul și nordul Europei. Și România se află în acest trend ascendent.
Se asociază frecvent (8% din cazuri) cu un nivel crescut de IgE seric total, istoric personal sau familial de atopie, astm bronșic sau/și rinită alergică.
Debutul este frecvent sub vârsta de 5 ani, formele severe apărând chiar sub 6 luni. Factorii genetici par a fi importanți:
• 70% au istoric familial pozitiv de atopie;
• Copii cu un părinte atopic au risc de 2-3 ori mai mare, iar cei cu ambii părinți au risc de 3-5 ori mai ridicat să facă dermatită atopică;
• Defecte genetice care condiționează disfuncții ale filaggrinei (componentă importantă a barierei lipidice), dar și ale celulelor imunității înnăscute și adaptative (dezvoltare preponderentă a inflamației de tip 2).
Factorii de mediu cum ar fi cei climatici, mediul urman, poluare, expunere precoce la microorganisme nepatogene și apa dură (bogată în calciu) constituie riscuri potențiale pentru dermatita atopică.
Interesant, copiii expuși la endotoxine, cei dați precoce la creșă, infestări helmintice, cu număr mare de frați, cei care locuiesc la ferme de animale și câini au risc mai mic de a face dermatita atopică.
Așadar, în dermatita atopică există o disfuncție importantă a barierei Epidermice (filaggrină, factor umectant natural, pierderea de apă transepidermică, claudina1 etc) la care se asociază o dereglare imună și inflamație de tip 2 (IL-4, IL-13, IL-22, IL-25, IL-31), alterare a microbiomului cutanat (infestare masivă cu stafilococ auriu hemolitic), dar și o serie de interacțiuni neuroimune care determină pruritul- simptom definitoriu al dermatitei atopice.
În perioada pandemiei s-a pus accent pe importanța vitaminei D. Există o legătura între vitamina D şi diversele afecțiuni ale pielii?
Vitamina D (calciferolul) este produsă în mod natural atunci când te expui la soare, dar se găsește și în anumite alimente.
Solubilă în grăsimi (nu și în apă), ea contribuie la absorbția calciului și fosforului în organism, ceea ce contribuie la sănătatea, întărirea sistemului osteo-articular, o bună funcționare a musculaturii, reduce riscul de fracturi (blochează hormonul paratiroidian), reduce riscul de a dezvolata anumite afecțiuni (osteoporoză, rahitism, scleroză multiplă, boli inflamatorii intestinale etc.), reglează sistemul cardiac, pierderea în greutate, reducerea depresiei și foarte important, creșterea imunității înnăscute și a celei adaptative a organismului. Potențează modul de acțiune a vitaminei A și C în organism și ajută la buna funcționare a unor glande precum tiroida, hipofiza, paratiroidele.
Dintre cele 5 tipuri de vitamina D, două par a fi cele mai importante - vitamina D2 (ergocalciferol) și vitamina D3
(obținută din 7 dehidrocolesterol sub acțiunea expunerii la raze ultraviolete).
Vitamina D are un rol foarte important în dezvoltarea armonioasă, fiziologică a pielii normale - cum ar fi o serie de elemente din matricea extracelulară, celulele reziduale ale pielii, vascularizația, sistemul neurocutanat, procesul de reparație, homeostazia imună etc. Poate preveni dezvoltarea unor forme severe ale bolilor inflamatorii cronice cutanate. Astfel, deficiența vitaminei D este asociată frecvent cu afecțiuni precum psoriazisul, dermatita atopică, hidradenita supurativă, boli autoimune sistemice cu afectare cutanată (lupus eritematos, sclerodermie sistemică, dermatomiozită, vasculite etc.), forme severe de afecțiuni din sindromul seboreic (acneea nodulară, acneea conglobată), rozaceea, maladii buloase (pemfigus, pemfigoid bulos etc.) și lista poate continua.
În același timp, deficitul de vitamina D poate afecta secundar pielea prin atingerea unor organe și sisteme (ex: sistemul endocrin, afecțiuni metabolice) care au strânse conexiuni cu buna funcționare a pielii.
Așadar, deficitul de vitamina D constituie o problemă într-o multitudine de boli cutanate legate de sistemul imun, inflamație, metabolism, hormoni, neuromediatori, etc.
Îmbătrânirea cutanată este direct legată de radiațiile solare. Care sunt cele mai periculoase radiații şi cum ar trebui să abordeze medicul dermatolog acest subiect în discuția cu pacientul?
Îmbătrânirea cutanată poate fi una fiziologică, legată de vârstă (chronologic aging) sau cea prematură, produsă prin expuneri repetate la radiațiile ultraviolete de la soare sau din surse artificiale (photoaging).
Rarisim apare în boli genetice cum ar fi progeria copilului (sindrom HurtchinsonGilford) sau a adultului (sindrom Werner).
Fotoîmătrânirea este produsă de expunerea continuă, pe termen lung la radiații UV. Arbitrar, spectrul radiațiilor ultraviolete (100-400 nm) este subdivizat în UVC (100-280 nm), UVB (280-320 nm) și UVA (320-400 nm).
Radiațiile UVC și o parte din UVB nu ating suprafața solului fiind absorbite de oxigen și ozon. Restul ajung la nivelul pământului, așadar și la nivelul pielii.
Pielea umană este concepută a fi eficientă în apărarea mediului nostru intern de acțiunea, uneori nocivă, a radiațiilor ultraviolete, prin structuri care absorb

aceste radiații, apărare antioxidativă enzimatică și neenzimatică, procese de reparație și înlăturare a celulelor afectare.
UVA – cele mai periculoase - ating dermul profund, în timp ce UVB sunt absorbite de epiderm, o mică parte atingând dermul superficial.
Dintre multiplele efecte ale radiațiilor ultraviolete la nivelul pielii amintesc:
• Modificări moleculare și geneticemutații ADN (cancere cutanate), riduri (afectarea colagenului și elastinei), teleangiectazii, pete de culoare maro, negre, roșii pe zone expuse la soare;
• Pigmentație, arsuri solare;
• Imunosupresie;
• Degradarea colagenului.
Rezultatul clinc al acestor modificări apare, mai ales, pe față, gât, decolteu și dosul mâinilor: teleangiectazii (nas, obraji, gât), spoturi pigmentare variate (pete, lentigine solare), pierderea tonusului cutanat în zonele fotoexpuse, riduri în jurul ochilor, gurii, riduri frontale care schimbă mimica (dezapropare, neplăcere), keratoze actinice, cancere cutanate.
O abordare corectă a medicului în discuția cu pacientul ar trebui să țină cont de câteva lucruri:
• Prevenția primară - reducerea factorilor de risc înainte de apariția bolii
▶ Utilizare de creme cu factor de protecție solară cu spectru larg (UVA, UVB, lumină albastră - 450 nm) în cantitate suficientă, înainte de expunerea la soare și reaplicare în caz de tranaspirație sau după ieșirea din apă;
▶ Haine cu protecție solară (UPF);
▶ Reducerea timpului de expunere la soare (mai ales între orele 10-16).
• Prevenția secundară – detectare precoce a bolii, prevenție, întârziere sau atenuare a condiției clinice simptomatice-administrare de retinoizi topici, antioxidanți (vitamina C, coenzima Q10), estrogeni, citokine, factori de creștere.
• Prevenția terțiară - ameliorarea efectelor bolii simptomatice existente - peeling chimic, micro-dermabraziune, laser ablativ sau non-ablativ, radiofrecvență, filler injectabil, toxină botulinică).




,
Compoziție:
PN- HPT®
Conținutul ambalajului:
1 seringă x 2ml
Ac:
Aplicații sugerate:
Adâncimea de injectare: Intradermică
Tehnica de injectare:
micropapule, liniară sau tehnica în evantai (ac)
Piele tânără - gât, frunte, mâini, cicatrici, cicatrici de acnee
Compoziție:
PN- HPT®
Conținutul ambalajului:
1 seringă x 2ml
Ac:
Aplicații sugerate:
Conturul ochilor, pleoape, riduri
superficiale
Compoziție
PN- HPT®
Conținutul ambalajului:
1 seringă x 2ml
Ac:
Aplicații sugerate: Păr, sprâncene
Compoziție
PN- HPT®
Conținutul ambalajului
Adâncimea de injectare:
Intradermică
Tehnica de injectare:
micropapule, liniară
sau tehnica în
evantai (ac)
Adâncimea de injectare:
Intradermică
Tehnica de injectare: micropapule sau liniară (ac)
zona mediană, cicatrici, cicatrici acneice
Adâncimea de injectare: Intradermică
1 seringă x 2ml
Ac:
Aplicații sugerate: Ten matur
și pielea deshidratată - fată,
Tehnica de injectare: micropapule, liniară sau în evantai (ac) Distribuit
Pentru mai multe informatii vizitati: www.croma.at

Croma Pharma Romania cromapharma_romania




Despre noutățile aduse de Congresul Național precum și despre activitatea SRD în acest an, stăm de vorbă cu Dr. Alin Nicolescu, Secretar General al SRD
Ce teme şi subiecte de actualitate vor fi abordate anul acesta în cadrul Congresului Național?
Anul acesta, în cadrul Congresului Național al Societății Române de Dermatologie, vor fi abordate teme foarte interesante, vor fi atinse subiecte despre schimbările de abordare în ceea ce înseamnă diagnosticul și tratamentul bolilor dermatologice. Vom discuta despre dermatita atopică, urticarii, hidradenita supurativă – o afecțiune dermatologică gravă, invalidantă. De asemenea, unele teme vor fi despre afecțiunile firului de păr – alopecia areată și despre vitiligo, afecțiuni care astăzi se află în stare avansată de studiu cu numeroase terapii inovative. Vom actualiză cunoștințele despre terapiile biologice, terapii cu moleculă mică cu mecanism intracelular. Vom aborda dermato-estetica – act medical care necesită o pregătire specială (atunci când se folosesc injectări sau anumite produse dermatocosmetice).
În cadrul congresului se vor desfășura sesiuni de chirurgie dermatologică și sesiuni de dermato-oncologie. Deci, se vor discuta multe subiecte de interes și sperăm ca acest congres să se ridice și chiar să depășească manifestările precedente. Ce speakeri aveti invitați şi care sunt noutățile prezentate de aceştia?
Ca și invitați, vor fi prezenți lideri de opinie, specialiști în hidradenita supurativă, în urticarie, cei care au participat la studiile clinice care au condus la aprobarea terapiilor în aceste afecțiuni.
Vin în România pentru a împărtăși din experiența profesională personală, mai ales în țările unde există avantajul aplicării acestor terapii înainte de a le folosi și noi.

Dorim să facem un schimb de experiență în ceea ce privește abordarea paci-
entului din punctul de vedere al fiecărei afecțiuni, precum și despre cum se gestionează diferențele legate de tipul de asigurări care se practică în diferite țări.
Vă rugăm să ne comunicați ce proiecte are SRD în desfăşurare?
SRD încheie anul acesta (sperăm cu succes) proiectul de prevalență în dermatita atopică, al doilea mare proiect de acest gen.
De asemenea, vom încheia prima fază a unui program suport pentru pacienți în ceea ce privește controlul bolilor dermatologice. Spun prima fază, deoarece el se va derula în continuare.
Alt proiect în care am fost implicați a fost cel de traducere a unui tratat internațional ce intră în curricula obligatorie de pregătire a rezidenților și a medicilor și care va fi distribuit gratuit colegilor noștri.
Avem în vedere dezvoltarea în continuare a registrelor. Pot spune că, în registrul de psoriazis, avem peste 11.000 pacienți introduși, în cel de urticarie cronică, peste 1.000 pacienți (într-un an calendaristic), și câteva sute de pacienți în cel de hidradenită supurativă.
Este foarte importantă această înregistrare deoarece, până să avem registrele, se considera că numărul pacienților este unul foarte mic, și astfel, cu ajutorul acestor registre, realizăm valoarea reală a pacienților cu aceste afecțiuni.
De asemenea, anul acesta vom avea o nouă conferință medicală care se va desfășura în luna octombrie, un Update în dermatologie, cu 3 teme: psoriazisul vulgar, dermatita atopică și acneea. Aceasta se dorește a fi o conferință interactivă, cu ateliere pentru activitatea practică, unde medicii vor putea exersa prin rotație diferite proceduri.
SRD a susținut mereu medicii rezidenți și pot spune că Reziderma este o manifestare de tradiție care a ajuns la o ediție avansată, și va avea loc în Oradea la sfârșitul lunii septembrie.
Profilaxia şi combaterea afecțiunilor dermatovenerologice reprezintă una dintre principalele misiuni pe care SRD şi le-a propus. Ce programe de prevenție desfăşoară SRD sau care sunt propunerile SRD în acest context?
Continuăm campaniile tradiționale, proiectele SRD fiind cele deja consacrate.
Euromelanoma Day este acum în desfășurare. Organizația Europeană Euromelanoma prin Societatea Română de Dermatologie a lansat o nouă campanie de prevenție “Folosiți Protecția?”, proiect ce are ca scop principal îmbunătățirea comportamentului asociat cu protecția solară în rândul adolescenților.
Există o strânsă legătură între arsurile pielii provocate de soare în copilăria și adolescența fiecăruia dintre noi și creșterea riscului de a dezvolta un melanom la maturitate, astfel încât, anul acesta, vom pune un accent deosebit pe factorul de prevenție în rândul acestor categorii de vârstă și totoda-
„Prevenția
Spray oral pe bază de Vitamina E cu acțiune antioxidantă

Protejează și menține mucoasa bucală în stare bună
Indicații:
- pentru igiena și sănătatea cavității bucale, în special în timpul sarcinii
- în caz de reacții alergice sau hiperactivitate a mucoasei, idiosincrazie
Fără arome, coloranți, conservanți, uleiuri esențiale
Testat pentru Nichel și Gluten
Compoziție: Caprylic/Capric Trigliceride,Tocopheryl acetate

Flacon 20 ml, Fără gaz

tă, sperăm ca în plan general să amplificăm gradul de conștientizare legat de prevenirea, diagnosticarea precoce și tratamentul cancerului de piele. Campania din acest an, ce poartă sloganul „Folosești protecție?” stabilește o legătură între expunerea cumulativă la radiațiile UV și riscul de cancer cutanat și încurajează publicul să efectueze autoexaminări lunare ale pielii. SRD este partener al UMF “Carol Davila” și Societatea Româna de Endocrinologie în organizarea campaniei „Asumă-ți să fii Sănătos!” - Corturi amplasate în 5 locații pe litoralul Marii Negre (Costinești, Olimp, Neptun, Saturn, Mangalia).
Mulțumim pe această cale celor doi parteneri și mai ales celor care s-au implicat, în special domnului Rector Prof. Dr. Viorel Jinga și doamnei Prorector Prof. Dr. Cătălina Poiană.
Avem numeroase alte participări la diverse activități umanitare, sportive, în care încercăm să explicăm că, și atunci când facem ceva bun pentru sănătate cum este sportul, trebuie să fim precauți mai ales la activitățile ce se desfășoară în aer liber deoarece suntem expuși razelor solare.

Un alt proiect este Ziua Mondială a Psoriazisului, pe 29 octombrie, când vom disemina noi informații despre această afecțiune, prin care dorim să conștientizăm populația că psoriazisul nu este contagios, iar pe pacienți că există tratamente inovatoare
care pot stopa boala. Apoi, aminteam puțin mai devreme de caravanele care merg către universități, acolo unde vom face cursuri de injectări, în proiectul comun cu Societatea Română de Chirurgie Estetică.
Ce parteneriate şi colaborări desfăşurați cu alte societăți academice naționale şi internaționale? Cum apreciați că poate fi îmbunătățită colaborarea cu colegii dumneavoastră din alte specialități medicale spre binele pacientului?
Colaborarea cu Academia Europeană de Dermatovenerologie (EADV) este una remarcabilă.
În ceea ce privește colegii din țară, pot spune că avem colaborari cu Societatea Română de Pneumologie, Societatea Română de Alergologie și Imunologie Clinică (SRAIC) cărora le mulțumim pe această cale.
Aș dori să menționez că am început o colaborare și cu SRPed pentru educarea populației încă din perioada copilariei.
Deasemeni, desfășurăm împreună cu SRCE cursuri comune de injectări și alte proceduri pe care le pot executa doar medicii.
Deorece psoriazisul este o patologie la granița dintre specialități, abordăm paci-
entul împreună cu medicii reumatologi, deci în parteneriat Societatea Română de Reumatologie.

Există deschidere din partea SRD și invităm societățile medicale din România să ni se alăture pentru a face totul în interesul pacienților noștri.
Toate campaniile SRD au demonstrat că rolul medicinei de prevenție este unul fundamental pentru integritatea sănătății fiecăruia dintre noi. Cât depinde de medici şi cât de sistemul medical o reuşită la acest capitol important?
Prevenția este un alt obiectiv important al SRD, și aș menționa că medicii au înțeles acest lucru și încearcă din ce în ce mai mult o abordare a pacientului nu doar personalizată, ci și predictivă, astfel încât să rezolve problemele medicale fără a le agrava alte afecțiuni.
Deasemeni, desfășurăm programele de sceening (deja cunoscute) pentru depistarea cancerelor cutanate.
În ceea ce privește relațiile cu autoritățile, pot spune că avem toată înțelegerea, susținerea și o colaborare excepțională în acest sens. Dovadă stau terapiile inovatoare care sunt puse la dispoziția noastră pentru tratarea pacienților.


Fără frosting || Fără exfloliere || Fără foto sensibilizare Primul dispozitiv de biorevitalizare fără ace
PRX-T33 este un dispozitiv medical care conține:

TCA 33% Acid kojic 5% Hidroxi-peroxid H2O2
• Biorevitalizare

• Foto-aging: revitalizarea pielii de pe față, gât, decolteu, corp
• Cicatrici atrofice
• Vergeturi
• Terapii combinate cu injectabile de biorevitalizare și fillere, microneedeling, laser fracțional diodă sau CO2, fire resorbabile PDO, PRP








Tratamentul se completează cu linia de produse de mentenanță pentru acasă

în arsenalul terapeutic românesc). Ustekinumab este un anticorp monoclonal anti IL-12/23, indicat atât la pacienți cu psoriazis în plăci moderat-sever, ce nu au răspuns la terapii convenționale, cât și la cei cu artrită psoriazică activă. Pornind de la rolul semnificativ pe care îl joacă IL-17 în patogenia psoriazisului, au fost descoperite numeroase terapii biologice ce țintesc această cale. În România sunt disponibile ixekizumab, secukinumab, și de curând bimekizumab, cel mai recent anti IL 17 aprobat pentru psoriazisul în plăci. Brodalumab nu este disponibil în țara noastră. Dintre tratamentele biologice mai recent introduse, în ultimii ani, în tratamentul psoriazisului în plăci fac parte agenții biologici anti IL-23, respectiv: risankizumab, guselkumab și tildrakizumab.
În abordarea terapeutică a psoriazisului sever la copii, în Europa cât și în țara noastră, este aprobat adalimumab (peste 4 ani), respectiv etanercept, ustekinumab și secukinumab (peste 6 ani).
O altă opțiune terpeutică în psoriazisul moderat sever dar și în artropatia psoriazică este Apremilastul, tratament oral, ce face parte din moleculele mici cu acțiune intracelulară, fiind un inhibitor de PDE4. Ca noutate terapeutică în tratamentul sistemic, tot cu administrare orală este deucravacitinib, un inhibitor de tirozin kinază 2 (TYK2), kinază intracelulară ce mediază calea IL-12, IL-23 și IFN tip I, citokine implicate în inflamație și răspunsul imun, care a fost aprobat în tratamentul psoriazisului în plăci moderat-sever în 2022.
De asemenea, în septembrie 2022 a fost aprobat spesolimab, un antagonist al receptorului IL-36, prima moleculă ce poate fi utilizată în tratamentul psoriazisului pustulos generalizat, formă de psoriazis cu un puternic impact atât fizic, cât și emoțional asupra pacientului.
Alegerea unui tratament optim poate fi dificilă uneori, în pofida multiplelor opțiunilor terapeutice disponibile, fiind necesară individualizarea tratamentului, ținând cont de forma psoriazisului, extindere, zonele afectate, durata evoluției bolii, vârsta și sexul pacientului, starea generală și comorbiditățile asociate.
Psoriazisul vulgar prezintă multiple implicații sistemice, recunoașterea și abordarea multidisciplinară a acestora îmbunătățește calitatea vieții acestor pacienți. Cele mai frecvente patologii asociate psoriazisului sunt: obezitatea (33,7 %), hipertensiune arterială (31,2%), boala cardiacă ischemică ( 3,3%), AVC (1,8%), dislipidemie (28,8%), diabet zaharat de tip II (13,9%), sindrom metabolic (28,3%), hipertrigliceridemie (45,7%). De aceea este necesară evaluarea periodică a indicelui de masă corporală, a tensiunii arteriale, nivelul seric al trigliceridelor, HDL-colesterol, glicemia sanguină.
Prezența artritei psoriazice la pacienții cu psoriazis variază între 6% și 42%. Pe langă predispoziția genetică un rol important în artropatia psoriazică îl joacă afluxul de citokine proinflamatorii, cu infiltrarea neutrofilică în plăcile de psoriazis și în membrana sinovială. De aceea este esențială evaluarea afectării articulare la toți pacienții.
Apariția diabetului zaharat de tip II se asociază cu durata de evoluție a psoriazisului. În contextul inflamației cronice, disfuncțiile endoteliale determină scăderea toleranței la glucoză.
Afectarea cardio-vasculară este mai frecventă la tinerii de sex masculin cu forme moderat severe de psoriazis. Psoriazisul este factor de risc independent pentru boala cardiacă ischemică, inflamația având rol în apariția aterogenezei coronariene și carotidiene. Mecanismul etiopatogenic implică prezența stresului oxidativ, IL 6 și nivelul crescut al proteinei C reactive, hiperhomocisteinemiei și factorii de risc cardio-vasculari. Acest risc scade la pacienții care urmează tratament cu Metotrexat sau tratamente biologice.
Boala pulmonară cronică obstructive - BPOC are o incidență mai mare la pacienții cu psoriazis pustulos generalizat și eritrodermic, la aceasta contribuind fumatul.
În țările nord-europene, prevalența psoriazisului este de 3-4% și a bolilor inflamatorii intestinale este 0,3 %.
Predispoziția genetică și disbioza cutanată-intestinală determină dezechilibre imunologice și inflamatorii locale cu apariția bolilor inflamatorii intestinale, care se pot asocia psoriazisului. Este esențial de știut că, în psoriazis, medicația anti IL 23 și anti IL17 au efecte benefice, dar în bolile inflamatorii intestinale asociate psoriazisului pentru medicația anti IL 17 este recomandată precauție în administrarea acestora.
Disfuncțiile hepato-biliare sunt mai frecvente la pacienții cu psoriazis pustulos față de populația generală. Clinic pot fi prezente colangita neutrofilică, steatoza hepatică, fibroza hepatică cu instalarea insuficienței hepatice. Screeningul hepatic este esențial având în vedere folosirea pe scară largă a terapiilor sistemice hepatotoxice. Majoritatea terapiilor biologice au un profil favorabil risc/beneficiu la cei cu fibroză hepatică. Se urmărește raportul risc/beneficiu individual și recomandările medicului gastro-enterolog.
Psoriazisul este dermatoza cea mai frecvent asociată cu depresia, fiind corelată cu valorile crescute de TNF α de la nivel cutanat. Un rol important în evaluarea aceasta îl are efectuarea periodică de DLQY. Alte asocieri cu psoriazisul pot fi scleroza multiplă, sindromul de apnee în somn, osteomielita, uveita anterioară.
Datorită dezechilibrelor imune la pacientul cu psoriazis, crește riscul de limfom cutanat cu celule T și limfom Hodgkin, mai ales la pacienții peste 65 ani. La aceasta contribuie fumatul, tratamentul cu ciclosporină și terapiile biologice. Riscul de carcinom spinocelular este de 14 ori mai crescut la pacienții expuți la tratamente PUVA.
Complianța la tratament implică adeziunea bolnavului la indicațiile medicale, care includ tratamentul medicamentos, regimul alimentar, modificarea stilului de viață, precum și acceptarea supravegherii medicale și a controlului periodic. De aceea, în cadrul bolii psoriazice, complianța la tratament este esențială pentru managementul bolii și poate îmbunătăți
semnificativ răspunsul clinic și calitatea vieții pacienților. Există numeroși factori și variabile care influențează complianța pacienților la tratament: o bună relație medic – pacient, încrederea în tratamentul prescris, cunoașterea modului de administrare.
Aderenţa terapeutică implică colaborarea voluntară a pacientului în consens cu planul terapeutic stabilit de medic și înțeles acceptat de pacient. De aceea, aderența la tratament este cel mai important factor care influențează pe termen lung rezultatele tratamentui și presupune participarea activă a pacientului, în relația medic - pacient. Factori importanți în aderența la tratament sunt statutul civil și socio-economic, nivelul de educație, cultura și satisfacția pacienților cu tratamentul prescris.
Non-aderența la tratament reprezintă o problemă cronică cu impact atât asupra cadrelor medicale cât și a pacienților în ceea ce privesc bolile care necesită medicație cronică, precum psoriazisul vulgar. Studiile arată că până la 40% dintre pacienți nu își administrează tratamentul corespunzător, ceea ce afectează răspunsul terapeutic în practica medicală. Complexitatea problemei constă în mulțimea de factori care influențează aderența. Majoritatea pacienților cu psoriazis încep tratamentul prin medicație topică. Pe de o parte, pacienții cu psoriazis vulgar cronic renunță la tratament din cauza ineficienței și consideră că nu vor obține un rezultat mai bun odată cu continuarea terapiei, în special în cazul terapiei topice. Unii pacienți consideră, în timp, că majoritatea tratamentelor topice nu sunt eficiente sau sunt consumatoare de timp.
Alegerea tratamentului inițial poate fi crucial pentru a asigura complianța pacientului la tratament pe termen lung. În cazul pacienților care urmează tratament topic pentru psoriazis s–a constatat că aceștia au tendința de a subdoza medicamentul, de a simplifica schema primită de la medic prin aplicarea unei cantități insuficiente de tratament topic sau de a sări peste aplicări din cauze diverse (cosmetic, confort). Pacienții cu psoriazis tind să fie mai complianți la terapii cu profil de siguranță ridicat și care necesită administrări mai puțin
frecvente. La fel ca și în cazul celorlalte tratamente topice sau sistemice, și în cazul terapiilor biologice aderența și persistența pacienților sunt suboptimale. Totuși, aderența la terapiile biologice tinde să fie mai mare decât în cazul celorlalte terapii. O mai bună înțelegere a determinanților aderenței la tratament poate ameliora răspunsul la terapia propusă pacientului cu psoriazis și poate duce la creșterea calității actului medical și satisfacției pacientului.
Numeroase strategii pentru îmbunătățirea complianței au fost sugerate și se subliniază că, pentru a spori înțelegerea complianței pacientului cu psoriazis, medicul trebuie să pună
accentul pe credințele și percepția pacientului în legătură cu boala și cu managementul acesteia. Îmbunătățirea relației medic – pacient poate ameliora complianța la tratament, încrederea pacientului în medic fiind strâns legată de comunicarea eficientă dintre cei doi. De multe ori pacienții primesc informații insuficiente despre diagnostic, administrarea tratamentului, durata și complicațiile bolii.
Medicul are datoria de a educa pacientul în legătură cu boala sa și de a oferi instrucțiuni detaliate asupra modului de administrare, aspect care poate crește complianța la tratament a pacienților cu psoriazis.

Formule unice*, inovatoare, testate clinic, pentru o mai bună imunitate.




Bacterii lactice naturale vii, cu rol în suplimentarea florei intestinale (Lactobacillus sakei Probio 65 5x10 UFC / doză) și 5 mg Zinc elementar.


Cu doar 1 plic/zi, ATOPFREE contribuie la menţinerea sănătăţii pielii și la funcţionarea normală a sistemului imunitar.





Abstract: With the onset of the COVID pandemic, a new pathology emerged in the pediatric field, namely the Pediatric Multisystem Inflammatory Syndrome temporally associated with SARS-CoV-2, which shares common clinical and paraclinical characteristics with Kawasaki Disease, an acute inflammatory pathology. By highlighting the diagnostic criteria and, implicitly, what sets them apart, doctors can establish an accurate diagnosis, allowing them to prescribe specialized care for each pathology individually.
Boala Kawasaki reprezintă o patologie inflamatorie acută, febrilă, autolimitată, de cauză necunoscută care afectează predominant copii cu vârstă mai mică de 5 ani. Implică leziuni inflamatorii asupra vaselor de calibru mediu, în special asupra arterelor coronare, ceea ce o face să fie una dintre cele mai comune cauze de boli cardiace dobândite în populația pediatrică din țările dezvoltate. Simptomele de conjunctivită bilaterală nonexudativă, hiperemia buzelor sau a mucoasei cavității bucale, erupțiile cutanate, modificările extremităților: la nivelul palmelor sau tălpilor, unde putem observa roșeață sau edeme, și limfadenopatiile laterocervicale pot apărea tipic după un scurt prodrom nespecific cu simptome respiratorii sau digestive. În literatură s-au definit două patologii înrudite cu Boala Kawasaki: Kawasaki incomplet, identificat în cazul copiilor sub 6 luni cu durată a croșetelor febrile peste 7 zile sau la copii de orice vârstă, cu durată a febrei de peste 5 zile, la care se validează doar 1 sau 2 criterii ale bolii Kawasaki; și Sindromul de Șoc Kawasaki, în care pe lângă caracteristicile bolii de bază, identificăm și o scădere cu minim 20% a presiunii arteriale sistolice și redistribuirea sângelui din periferie.
Odată cu apariția Pandemiei COVID la sfârșitul anului 2019, în aprilie 2020 și-a făcut apariția o nouă patologie în sfe-

ra pediatrică, și anume Sindromul Inflamator Multisistemic Pediatric temporal asociat cu virusul SARS-CoV-2, cu prescurtarea internațională PIMS-TS. Încă nu a fost formulată o definiție unanim acceptată, dar ultimele revizuiri realizate de CDC (Centers for Disease Control), se apropie de criteriile WHO (World Health Organization), care cuprind în definirea bolii următoarele aspecte: febra, prezența sindromului inflamator, a cel puțin două afectări de sisteme, dovada infectării sau expunerii la virusul SARS-CoV-2, și excluderea altor diagnostice diferențiale.
Cele două patologii prezintă unele carcateristici clinice și paraclinice comune, astfel încât este necesar un diagnostic diferențial riguros între cele două, pentru ca pacientul să primească terapia optimă și să se cunoască posibilele efecte secundare și pe termen lung.
O variabilă importantă care apare în definirea acestor boli o reprezintă vârsta pacientului: boala Kawasaki apare predominant la copii cu vârstă sub 5 ani, cu o medie de 2 ani, în timp ce PIMS-TS apare la copii cu vârstă de peste 5 ani, cu o medie a vârstelor de aproximativ 11 ani.
Ambele patologii sunt influențate de bagajul genetic al pacientului, astfel încât Boala Kawasaki are o incidență mai mare în Asia de Est și la cei care provin din descendenți asiatici, în comparație cu PIMS-TS, care afectează în mod disproporționat copiii negri sau hispanici, regăsindu-se într-un număr scăzut de cazuri la populația asiatică.
Frecvența cu care manifestările clinice se regăsesc mai mult în cadrul unei boli față de cealaltă reprezintă un alt criteriu
de diagnostic diferențial. Astfel, simptomele care afectează sistemul gastro-intestinal, precum durerea abdominală, sunt mai prezente la PIMS-TS, în comparație cu Boala Kawasaki, unde problemele din sfera dermatologică, precum erupții, eritemul extremităților, sunt caracteristici frecvent regăsite în tabloul clinic.
Tabloul paraclinic este un instrument foarte util atât în diagnosticul pozitiv, cât și diferențial al unor patologii. În cazul de față, există anumite diferențe între analizele de laborator ale celor două boli, care ne ajută să le diferențiem: astfel, în cazul Bolii Kawasaki întâlnim leucocitoză, față de PIMS-TS, unde numărul total al leucocitelor poate fi normal sau scăzut; ambele prezintă anemie intrainfecțioasă, care se remite cu tratamentul optim, sindromul biologic inflamator, evidențiat prin viteza de sedimentare a hematiilor și Proteina C reactivă, este mai important în PIMS-TS. În ceea ce privește numărul trombocitelor, cele două patologii se află la poli opuși: în PIMS-TS avem trombocitopenie, iar în Kawasaki avem trombocitoză, cu excepția cazului în care patologia se complică cu coagulare diseminată intravasculară. Hipoalbuminemia este o caracteristică întâlnită la ambele boli, fiind mai pronunțată în PIMS-TS, unde se regăsesc în analizele de laborator și troponina, peptidul natriuretic B, markeri ai afectării cardiace. De asemenea, un element foarte important din tabloul paraclinic al PIMS-TS îl reprezintă un test pozitiv SARS-COV-2, sau un test care să demonstreze expunerea la acest virus.
Coroborând diferențele dintre cele două patologii, putem formula criterii-
le necesare pentru a susține diagnosticul fiecăreia dintre ele: Boala Kawasaki are că element central febra, având caracteristice o durată mare - de minim 5 zile, valori mari, de peste 39 de grade Celsius, și faptul că este remitentă. Alături de ea regăsim: modificări ale extremităților, cu eritemul palmelor și tălpilor, modificări îndurate dureroase la nivelul mâinilor sau picioarelor, și descuamări ale degetelor; erupția, foarte caracteristică, apare în primele 5 zile de la debutul croșetelor febrile, la nivelul trunchiului și extremităților, sub forma unor zone maculo-papulare difuze, cel mai frecvent, eritrodermia scarlatiformă sau erupție asemănătoare eritemului polimorf, frecvent, și erupții urticariene sau fine micropustule, rare; Conjunctivita bilaterală apare la nivelul foiței anterioare a sclerei, e nonexudativă. La nivelul mucoasei cavității bucale pot apărea: eritem, fisuri, sângerări ale buzelor, limba “căpșună”- cu papile fungiforme proeminente. Limfadenopatiile cervicale apar de obicei unilateral, cu diametru mai mare de 1.5 cm, limitate la triunghiul cervical anterior.
În ceea ce privește PIMS-TS, putem susține diagnosticul prin criteriile prezentate atât de CDC, cât și de WHO: febra, un element obligatoriu, cu o durată mai mare de 3 zile și cu valori de peste 38 de grade Celsius; afectarea multisistemică - prin implicarea a cel puțin 2 sisteme, evidențiată prin următoarele: dermatologic - erupție, conjunctivită, semne inflamatorii mucocutanate (la nivel oral, mâi-
ni sau picioare), cardiovascular - creșterea troponinelor sau al peptidului natriuretic B, scăderea fracției de ejecție, anevrisme, ectazii; hematologic - prin coagulopatii (creșterea D-dimerilor, a TP, aPTT), gastrointestinal: dureri abdominale, diaree, vomă; sau șoc. Un alt criteriu este reprezentat de prezența sindromului biologic inflamator, sugerat de valori crescute ale Proteinei C reactive, Vitezei de sedimentare a hematiilor, a procalcitoninei. Confirmarea infecției sau expunerii la virusul SARS-COV-2 poate fi realizată cu ajutorul: RT PCR, a serologiei, a testelor de tip antigen sau a contactului cu o persoană cunoscută cu infecție SARS-COV-2. De asemenea, pentru a confirma PIMS-TS, trebuie excluse orice alte patologii infecțioase ce ar putea cauza inflamație - precum sepsis bacterian sau sindroame toxico-septice stafilococice sau streptococice.
Tratamentul celor două patologii prezintă un punct comun: imunoglobulinele administrate intravenos. În cazul bolii Kawasaki acestea se administrează în doză mare, unică, preferabil în primele 10 zile de boală, împreună cu aspirina, administrată la 6 ore. În caz de rezistență la imunoglobuline se apelează la corticosteroizi. În cazul PIMS-TS, imunoglobulinele se asociază cu corticoterapia. În cazurile ușoare, fără dovezi de afectare cardiacă, se pot da doar imunoglobuline, dar cu cât cazul este mai complicat, glucocorticoizii se administrează în doze descrescânde, înainte de a administra imunoglobuline.
Reunind informațiile prezentate, putem concluziona faptul că cele două patologii reunesc aspecte clinice și paraclinice comune, dar populația pediatrică trebuie să primească îngrijirile specifice fiecărei patologii în parte. Din acest motiv, atenția medicului trebuie să se axeze pe elementele ce le diferențiază pe cele două, având în vedere această perioadă post-Pandemie de COVID-19, astfel încât să stabilească diagnosticul corect.

1. Alghamdi KT, Waggass RA, Aga SS, Alrohaili AA, Alaidroos AH, Alghamdi MD, Algamdi MK, Alghamdi AT. 2021. „The Most Common Clinical Features of Kawasaki Disease Patients in King Abdulaziz Medical City.” Cureus.
2. Brian W. McCrindle, Anne H. Rowley, Jane W. 2017. „Diagnosis, Treatment, and Long-Term Management of Kawasaki Disease: A Scientific Statement for Health Professionals From the American Heart Association.” Circulation .
3. Elizabeth M. Dufort, M.D., Emilia H. Koumans, M.D., M.P.H. 2020. „Multisystem Inflammatory Syndrome in Children in New York State.”The New England Journal of Medicine.
4. Mary Beth F Son, MDKevin Friedman, MD. 2023. „COVID-19: Multisystem inflammatory syndrome in children (MIS-C) clinical features, evaluation, and diagnosis.” up-to-date.
5. Ming-Ming Zhang, Lin Shi, Xiao-Hui Li, Yao Lin, and Yang Liu. 2017. „Clinical Analysis of Kawasaki Disease Shock Syndrome.” Chinese Medical Journal.
6. Singh-Grewal D, Lucas R, McCarthy K, Cheng AC, Wood N, Ostring G, Britton P, Crawford N, Burgner D. 2020. „Update on the COVID-19-associated inflammatory syndrome in children and adolescents; paediatric inflammatory multisystem syndrome-temporally associated with SARS-CoV-2.” J Paediatr Child Health.

Abstract: It is generaly accepted that stem cells are at the origin of cancers, including cutaneous ones. Every different types of cells of the skin and mucous membranes could generate a cancer; in practice, the most frecvent ones are basocellular carcinomas and squamous cell carcinomas are reunited under the name „non-melanomatous skin cancers“ (NMSC) and the most aggressive cancers represented by malignant melanomas represent the second group (MM). For both categories the diagnostic is based on clinical signs, dermoscopic examinations and anatomopathological aspects. Early types of NMSC are treated by cryocauterisation, electrodessication or laser distruction. More difficult cases have the main indication surgical excision with control of possibles metastases in local lymphatic nodes. Alternatively the radiotherapy is effective in both. If patients can not support or refuse surgery or radiotherapy, topical applications of cytostatics (5-fluoro-uracil) or, better, immunomodulators (imiquimod) are indicated. For NMSC with metastases biological therapies sometimes associated with chemotherapy are available now: vismodegib and sonidegib (CBC), pembrolizumab and cisplatinum/ docetaxel (CSC). For MM, even the most precocious cases have the surgery fallow by corporal medical imaging (CT, PETCT, RMN) as the main indication. In metastatic cases biological new therapies are useful: Vemurafenib for BRAF + cases, Pembrolizumab, Nivolumab, Ipilimumab, Bevacizumab. Personalised ARN vaccines against surface antigenes of melanoblastes are a great hope for future.
UMF. „Iuliu Hațieganu” Cluj, Dept. Dermatologie

Tegumentul împreună cu mucoasele corespunzătoare este cel mai greu organ al corpului, având 16 kg în medie, și unul din cele mai extinse în suprafață, totalizând circa 1,9 m pătrați. Acest lucru înseamnă că posedă un mare număr de celule stem, activate în cazul diverselor injurii cutaneo-mucoase, în scop fiziologic reparator. Aceleași celule stem stau, după majoritatea teoriilor actuale, și la originea diverselor neoplazii cutaneo-mucoase, prin inițierea de diviziuni celulare necontrolate, sub acțiunea factorilor oncogeni externi sau/și interni. Tegumentul este totodată și un organ expus direct la acțiunea factorilor oncogeni de mediu, însuși rolul său fundamental fiind acela de interfață (o barieră interactivă) între mediul intern al organismului și mediul exterior. Tegumentul implică o
structură complexă, cu numeroase populații celulare diverse care conlucrează pentru asigurarea diverselor funcții vitale, barieră, protecție actinică, chimică, biologică, sensibilitate, homeostazie termică și altele. Oricare din aceste populații celulare poate genera o neoplazie specifică: keratinocite, melanocite, fibroblaști, mastocite, celule endoteliale, limfocite, receptori nervoși cum sunt celulele Merkel, macrofage - dar cu frecvențe foarte diferite. Cancerele cutaneo-mucoase de tip fibrosarcoame, angioendotelioame, cu celule Merkel sau mastocite sunt rare, în timp ce cancerele provenind din celule stem keratinocitare sau melanocitare sunt extrem de frecvente. Din motive practice de tratament al celor mai frecvente neoplazii cutanate, acestea au fost clasificate în mare în două categorii: carcinoame cutanate non-melanomatoase (CCNM) și respectiv carcinoame cutanate melanomatoase (MM).
În prima categorie intră carcinoamele bazocelulare (CBC) și carcinoamele spinocelulare (CSC) ca fiind de departe cele mai frecvente (și cu principii terape-
utice bine codificate), precum și rarități: carcinomul cu celule Merkel (multiplu recidivant, intens metastazant, intratabil deocamdată), neurinoame maligne, mastocitoame maligne și altele, toate la ora actuală fără vreun tratament eficace și bine codificat.
Categoria melanoamelor maligne este a doua ca frecvență, sunt neoplazii cu proceduri de tratament bine codificate și eficace.
Două grupuri aparte sunt formate de neoplaziile cu punct de plecare în limfocitele permanent rezidente în ganglionii limfatici cutaneo-mucoși, care formează grupul limfocitoamelor cutanate și respectiv neoplaziile cu punct de plecare în macrofagele locale, care formează grupul histiocitozelor X, ambele rare și dificil de tratat.
Carcinoamele bazocelulare derivă cel mai probabil din celulele-stem foliculare situate în zona bulge a sacului folicular. În esență aceste carcinoame sunt un fel de foliculogeneză aberantă, motiv pentru care nu apar niciodată pe mucoase; cresc foarte lent și, fapt important, metastazează extrem de rar, deoarece produc intrinsec o pseudomembrană bazală care
împiedică contactul cu rețeaua limfatică sau/și vasculară locală. Ca atare, perioada de intervenție utilă se întinde de-a lungul mai multor ani de la debut.
Carcinoamele spinocelulare derivă din celulele-stem epidermice, adesea prin evoluția unor leziuni preneoplazice cum sunt keratozele actinice, apar și pe mucoase, unde uneori sunt implicate virusurile HPV oncogene, cresc mai rapid, perioada de intervenție utilă se restrânge la 6 – 12 luni, iau contact direct cu rețeaua limfatică locală și metastazează în circa 15 -20% din cazuri în ganglionii limfatici loco-regionali și rar, sub 5% din cazuri, în diverse organe interne pe cale sanguină. O localizare frecventă este pe buza inferioară deoarece aceasta primește direct radiația ultravioletă solară.
Se descriu rar și carcinoame mixte bazo și spinocelulare, cu evoluția mai agresivă tipică unui CSC.
Diagnosticul se bazează pe semnele clinice, dermoscopia vascularizației tumorale și examenul histologic al biopsiei/piesei de excizie.
Tratamentul formelor incipiente implică diverse metode de distrucție sau înlăturare a tumorii suspecte: se poate chiureta (metodă acceptată doar în SUA), criocauteriza/diatermocauteriza electric sau prin radiofrecvență, vaporiza prin laser. Indicația de elecție este eliminarea chirurgicală cu controlul anatomopatologic al marginilor și explorări imagistice pentru eventuale metastaze. Deoarece rata de recidivă în cazul CBC este de peste 10% la 5 ani, indiferent de metodele de mai sus, este preferabilă excizia chirurgicală după metoda Mohs, cu controlul intraoperator al marginilor și profunzimii masei tumorale pe secțiuni multiple, efectuate orizontal și nu vertical.
Alternativa pentru pacienții la care nu se poate practica chirurgia sau o refuză este radioterapia de contact, cu doze totalizând 6 – 12 Grey, ambele cancere fiind deosebit de radiosensibile.
O situație deosebită apare în cazul pacienților cu numeroase keratoze actinice și eventual mai multe focare de transformare malignă în CSC, practic vorbim despre un câmp de cancerizare care trebuie eliminat; analog, alți pacienți pot prezenta concomitent multiple tumori maligne cutanate (atât CSC cât și CBC) pe fondul unor genodermatoze predispozante – mai ales sindromul ne-
vilor bazocelulari și respectiv xeroderma pigmentosum. În aceste situații se preferă distrucția tumorilor și a câmpului de cancerizare prin terapie fotodinamică (pentru a evita dozele mari de iradiere care ar fi necesare): acidul aminolevulinic, ca precursor porfirinic, este aplicat pe piele, devine intrakeratinocitar porfirină fotodinamică și se iluminează aria cu lumină roșie sau albastră pentru activare.
Tratamente morbistatice pot fi utilizate la pacienți care refuză orice intervenție sau comorbiditățile prezente nu permit altceva: aplicare de Imiquimod cremă pentru stimularea reactivității sistemului imun local. La limită se pot încerca și citostatice local, de exemplu 5-fluoro-uracil.
Metastazările beneficiază pe lângă intervențiile chirurgicale de terapii biologice țintite. Pentru CBC metastazat s-au dovedit parțial eficace terapiile de blocare a căii hedgehog cu vismodegib, respectiv sonidegib și de blocare a punctului de control al morții celulare programate cu cemiplimab și nivolumab. Pentru CSC metastazat au funcționat cu succes parțial inhibiția factorului de creștere epidermică prin cetuximab, respectiv dintre inhibitorii punctului de control este util pembrolizumabul.Dintre citostaticele clasice s-au dovedit parțial utile combinațiile carboplatin cu paclitaxel pentru CBC, respectiv cisplatin plus docetaxel pentru CSC.
Melanomul malign cutaneo-mucos derivă probabil din melanocite stem epidermice, de vreme ce 70% din cazuri apar pe tegument în prealabil indemn și doar 30% pe nevi melanocitari pre-existenți. Melanoblastele au încă din perioada de embriogeneză capacitatea de a a migra activ, astfel încât tumora melanocitară intră precoce și activ în contact practic concomitent cu rețeaua limfatică și cea vasculară subiacente, metastazarea fiind frecventă și rapidă.
Terapeutic excizia chirurgicală cu margine de siguranță inițială de 5 mm a tumorii suspecte este obligatorie, indiferent de starea clinică a bolnavului sau de opțiunile sale, dacă se are în vedere supraviețuirea la 5 ani. Examenul anatomopatologic este standardul de aur pentru diagnostic (uneori extrem de dificil, necesitând colorații imunohistochimice speciale) și oferă indicele Breslow (= grosimea tumorii) în funcție de care se stabilește toată conduita terapeutică ulterioară,
respectiv necesitatea investigațiilor imagistice detaliate ale ganglionilor limfatici peritumorali (scintigrafie), a celor locoregionali (ecografie de orientare urmată de scintigrafii) și a întregului corp (preferabil PET-CT) pentru identificarea eventualelor metastaze actuale, cu repetarea anuală a scanării corporale pentru evidențierea metastazelor apărute ulterior.
Caracterele embrionare recâștigate explică și relativa radiorezistență cât și răspunsul slab la citostatice în cazul melanoamelor. Mai active s-au dovedit tratamentele de imunostimulare nespecifică, actual rămâne validă administrarea de interferon – gama, cu oarecare efecte benefice inconstante.
Speranțele terapeutice actuale se îndreaptă către terapiile biologice cu efect țintit. Enumerăm pe scurt cele uzuale și de perspectivă imediată:
a. Inhibiția exprimării genei BRAF V600, modificată în circa 50% din MM – Vemurafenib;
b. Inhibitori ai punctului de control pentru moartea celulară programată – Ipilimumab, Nivolumab, Pembrolizumab;
c. Blocanți ai creșterii celulare – Bevacizumab;
d. În studiu la Johns Hopkins Hospital terapia pre-operatorie cu asocierea Nivolumab cu Relatlimab (anti-LAG 3);
e. Producerea de vaccinuri personalizate antitumorale – Moderna produce în 8 săptămâni un vaccin ARN personal, pentru circa 34 de antigene tumorale, obținute din piesa de excizie a pacientului, cu rezultate satisfăcătoare în reducerea ratei de recidivă.
Profilaxia primară pentru toate carcinoamele cutanate este un succes odată cu acceptarea largă de către populație a obiceiului de protecție solară și estimăm o altă îmbunătățire dacă și vaccinul anti-HPV va fi folosit pe larg. Există o speranță pentru vaccinuri probabil ARN antitumorale de protecție.
Profilaxia secundară rezidă actualmente în rețeaua dermatologică care oferă examinări dermoscopice de calitate, identificând riscul tumoral cu ani înainte de validare, cu posibilitatea de a folosi programe de inteligență artificială aplicate la aparatura ce examinează automat toată suprafața corpului (total body maping), ușurând enorm munca zilnică a dermatologilor.
Peptidele biologic active din glanda timusului sunt foarte apreciate în medicina complementară, în primul rând datorită caracteristicilor lor de restabilire a imunității. Sunt utilizate pentru a stimula propriul sistem imunitar al organismului de a produce limfocite B și limfocite T, în caz de boală. Numeroase observații și studii au arătat că peptidele timice pot fi, de asemenea, utilizate cu succes în alte domenii relevante dpdv medical. Studiile derulate confirmă încă odată aplicarea terapeutică a peptidelor timice în lupta cu pierderea părului.
Complexul activ patentat de peptide timice, GKL-02
Complexul patentat de peptide timice, GKL-02, aflat în compozitia produselor THYMUSKIN®, este complexul care imită extractul natural de timus și nu conține ingrediente derivate de la animale.
În această bibliotecă de peptide, treizeci și trei de derivați de aminoacizi sunt combinați chimic într-o manieră statistică unul cu celălalt și, în cele din urmă, combinați fizic cu șaptesprezece aminoacizi naturali, fie ca atare, fie ca sărurile lor și ca derivați ai acestora. Greutatea moleculară medie a peptidelor individuale este cuprinsă între 180 și 600 daltoni, facilitând astfel penetrarea prin stratul folicular al pielii după ce a fost aplicat pe scalp.
Ingredientul inovator patentat GKL-02 este responsabil în primul rând pentru revitalizarea și regenerarea părului, precum și pentru susținerea creșterii noilor fire de păr. Hidratarea și îngrijirea firului se realizează prin extracte naturale, așa cum sunt cofeina, vitamina E și urzica. Formula este completată de pantenol și proteine vegetale.
dermatologic
Thymuskin este sistemul dermatologic care combate căderea părului și activează o nouă creștere a părului atât pentru bărbați, cât și pentru femei. Conține Șampon utilizat în combinație cu Serul Thymuskin, princi-
palul responsabil de regenerarea și revitalizarea firelor de păr. Cele 3 linii de produse THYMUSKIN – CLASSIC, MED și FORTE - sunt perfect adaptate pentru fiecare tip de cădere a părului.
Este foarte eficient, oferă toleranță foarte bună pentru diferite tipuri de căderea părului și nu are efecte secundare chiar la utilizare îndelungată.
Studiile preclinice au relevat efectul imunologic al THYMUSKIN asupra foliculilor piloși, așa cum este tipic pentru preparatul timic.
• Întărește și activează apărarea imunitară a celulelor pielii și părului
• Crește vitalitatea celulară și reduce, sau chiar stopează, moartea celulelor din matricea firului de păr
• Îmbunătățesc migrarea celulară în rădăcina firului de păr în timpul fazei de creștere (faza anagenă)
• Foliculii piloși încă sunt intacți sunt reactivați, se formează noi fire de păr, iar faza de creștere este prelungită semnificativ
• În acest fel Thymuskin susține formarea a noi fire de păr și le întărește pe cele existente Astfel, preparatele Thymuskin pot reactiva creșterea părului în zonele lipsite de păr care sunt prezente de mai puțin de 3 ani. Liniile de produse THYMUSKIN®
Studiile și cercetările științifice observaționale controlate efectuate pe mai mult de 1.000 de bărbați și femei în cadrul clinicilor de dermatologie și clinicilor universitare din Germania și la nivel internațional au verificat eficacitatea Thymuskin asupra tuturor formelor de cădere a părului.
Rata de succes împotriva căderii părului în caz de alopecie androgenică, telogen effluvium, alopecia areată și difuză, și chiar forme ușoare de alopecie induse de medicamente citostatice este de peste 90%, fără efecte secundare chiar și în cazul utilizării pe termen lung.
THYMUSKIN® CLASSIC Recomandat pentru utilizarea generală


împotriva căderii părului,
• Eficient împotriva tuturor tipurilor
și etapelor de cădere a părului
• În special pentru păr și scalp normal spre gras
• Rezultate foarte eficiente, de ex. pentru căderea părului androgenică (ereditară), păr rar
THYMUSKIN® MED


Recomandat pentru tratament regenerator în caz de alopecie circulară & difuză
• Aplicabil împotriva pierderii puternice a părului și a petelor de calviție
• În special pentru păr și scalp sensibil sau uscat
• Conținut crescut +25% de substanță activăpeptida timică GKL-02
• Aplicarea este potrivită pentru copiii de la 3 ani, precum și în timpul sarcinii și alăptării
THYMUSKIN® FORTE

Recomandat ca
tratament regenerator în caz de alopecie asociată chimioterapiei
și alopecie difuză
• Aplicabil împotriva pierderii puternice a părului și a petelor de calviție
• În special pentru un scalp deteriorat
• Conținut crescut +100% de substanță activă - peptida timică GKL-02
THYMUSKIN®, produs în Germania, este eficient împotriva căderii părului de peste 30 de ani, devenind unul dintre liderii mondiali în tratamentul pentru căderea părului și pentru regenerarea noilor fire de
Vă mulțumim pentru încredere! Pharmconnect Services
+40 720 110 363; office@pharmconnect.ro
www.pharmconnect.ro; www.onconect.ro





EMTONE tratează în profunzime cauzele, în loc să suprime simptomele. Acesta conduce la rezultate imediate și de durată. EMTONE aduce o combinaţie revoluţionară de două tehnologii dovedite, ceea ce îl face să fie primul și singurul dispozitiv care tratează toate cele 5 cauze ale celulitei.
Înainte
 După al 4-lea tratament. Imagini: Dr. Marc Salzman
După EMTONE Înainte
Rezultat la 3 luni, după 4 tratamente. Imagini: Dr. Klaus Fritz
După EMTONE
După al 4-lea tratament. Imagini: Dr. Marc Salzman
După EMTONE Înainte
Rezultat la 3 luni, după 4 tratamente. Imagini: Dr. Klaus Fritz
După EMTONE
Vitiligo-ul este definit ca o dermatoză cu predispoziție genetică, în cadrul căreia celulele pigmentogene sunt inhibate în funcția lor de a produce pigment. Inhibiția se realizează prin mecanisme psihice, endocrine, redox, metabolice și imunologice.

Mecanismele redox sunt major implicate deoarece în vitiligo există o inflamație cronică tisulară, generată major prin mecanismele autoimmune dar și prin cele metabolice. În clinica noastră, utilizând dispozitive adecvate, determinăm nivelul agresiunii oxidative, nivelul prezenței și implicit nevoia de antioxidanți precum și nivelul acidozei tisulare. Cunoscând acești parametri, echilibrăm prin dietă și printr-o terapie personalizată, atât antioxidanții cât și acidoza tisulară, reducând nivelul inflamației cronice tisulare.
determinarea alergiilor alimentare, a intoleranțelor și disfuncțiilor enzimatice metabolice și de detoxifiere, reprezintă un punct important în terapia actuală a vitiligo-ului.
Dificultatea tratmentului vitiligo-ului rezidă din aceea că trebuie tratate, în același timp, toate cele cinci mecanisme, adică trebuie o terapie complexă și de multe ori de lungă durată, luni sau chiar ani.
În abordarea terapiei mecanismului neuropsihic, de mare interes sunt anxioliticele, rechilibrantele ritmului circadian veghe–somn dar și echilibrantele calității somnului.
Investigarea funcției endocrine este deosebit de utilă în vitiligo și mai ales funcția tiroidiană dar foarte importantă este echilibrarea ionică de care depinde excitabilitatea neuro-musculară (calciu, magneziu, potasiu).
Mecanismele imune sunt major implicate, multe teorii și clasificări actuale plasând vitiligo-ul în categoria maladiilior autoimune. Investigația imunologică generală,

Din analiza mecanismelor patogenice se impune necesitatea unei terapii complexe sistemice, metabolice şi locale. În cadrul terapiilor locale, de mare utilitate s-au dovedit inhibitorii de calcineurină şi dermatocorticoizii asociați cu terapie fizicală cu Raze UVBnarrow band şi/sau dispozitivele LED.
În ultimii ani au apărut și pe piața românească produsele pigmentogene cu extracte concentrate de piper negru dar și produse conținând cei 12 aminoacizi importanți metabolismului pigmentogen.
Manipulările de transplant de celule pigmentogene, celule stem și/sau terapiile cu exozomi se asociază din ce în ce mai pregnant în panoplia complexă a terapiei vitiligo-ului.
Dermatocosmeticele își au un loc bine stabilit în terapia vitiligo-ului.
Pentru a ajuta pacienții nostril, am creat în gama Deuteia Lux, o gamă unică în lume pe bază de Apă Echilibrată în Deuteriu (apă vie) și asociații complexe de principii active naturale - Deuteria Lux cremă hidratantă și emolientă pentru corp, Deuteria Lux cremă pentru ten sensibil și săpunul Deuteria Lux cu pH5,5, gamă care a trecut cu succes proba timpului, aducând beneficii deosebite pacienților noștri cu vitiligo.

Produs cosmetic medical conceput pentru îngrijirea zilnică a tenului sensibil, iritat și intolerant, conținând constituenți naturali (carbohidrați) similari cu cei din compoziția fiziologică a stratului cornos al epidermului normal. Echilibrează metabolismele energetice, lipidice și glucidice ale tenului. Are acțiune de elecție împotriva simptomelor clasice ale tenului sensibil: roșeața, usturimile, înțepăturile, mâncărimile (pruritul), lipsa de strălucire. Are proprietăți hidratante și antiiritante excelente și reface stratul de grăsimi protectoare cutanate. Împiedică apariția ridurilor și redă aspectul suplu și mătăsos al pielii. Echilibrează balanța hidrică a tenului și crește tonusul cutanat. Se folosește dimineața și seara, pe pielea curățată cu produsele Deuteria Lux.

Produs cosmetic pentru îngrijirea zilnica a corpului. Are efecte emoliente, calmante, antioxidante și hidratante excelente.


Mod de prezentare: Borcan 200 ml. Acest produs nu a fost testat pe animale. Testat dermatologic.
Natural și hrănitor are la bază o formulă fără săpun, cu pH 5,5 care este îmbogățită cu Colagen, D-Panthenol, extracte naturale de Aloe, Urzică și Mușetel.

Spală blând, hrănește și hidratează pielea inclusiv cea sensibilă și iritată.
Ingrediente: Extract de Aloe, Urzică, Mușețel Fără parfum, coloranți și parabeni.









Testele Patch reprezintă un important instrument în investigarea și diagnosticarea dermatitelor de contact. Acest tip de testare este semni cativ mai relevantă pentru diagnostic deoarece se folosesc substanţe standardizate, de o foarte bună calitate. Substanţele utilizate au cea mai înaltă puritate. Particule extrem de ne, din aceste substanţe, sunt incorporate în vaselina albă utilizată ca vehicul.

Substanţele, astfel preparate, sunt prezentate în seringi de polipropilen de 5 ml, pe când cele sub formă de soluţie lichidă sunt prezentate în acoane de polipropilen de 10 ml cu picurator.
Vaselina utilizată ca vehicul este Penreco Snow White, considerată cea mai pură de pe piaţă conform An Dooms-Goossens (Allergic contact dermatitis to ingredients used in topical applied pharmaceutical products and cosmetics: Katholieke Universiteit, Leuven, 1982; Thesis).
Haptenele produse de Chemotechnique Diagnostics sunt dintre cele mai pure, mai omogene, fără contaminare externă.

Aceeași rmă furnizează Skin Marker-i speciali, pentru marcarea locurilor patch-testelor pe tegument - Chemo Skin Markers™ - Medium.

Acești markeri conţin violet de gențiană, care este non-toxică, non-iritantă și nu pătrunde în piele, oferind totodată persistenţa culorii pe tegument.
Chemotechnique Diagnostics mai produce un Nickel Spot Test (Dimethylglyoxime) pentru detectarea nickelului liber și Cobalt Spot Test (Nitroso R sare) pentru detectarea cobaltului liber în obiectele de metal.
Distribuitor autorizat:
BALMED S.R.L. Tel/fax: +4 021 327 52 69 ww w.balmed.ro

copiilor născuți prin naștere vaginală, predomină Lactobacillus și Bifidobacterium, în timp ce la cei născuți prin cezariană predomină Staphylococcus și Streptococcus.
Un studiu efectuat pe un lot de 129 de copii cu vârste de până la 6 luni a arătat că la cei diagnosticați cu dermatită atopică numărul de bacterii din scaun era mai mic decât al celor sănătoși. De asemenea, un alt studiu a arătat că numărul de Bifidobacterium a fost semnificativ mai scăzut la pacienții cu dermatită atopică, în comparație cu cei sănătoși, acesta variind și în funcție de severitatea bolii. Aceste studii sugerează o posibilă legătură între microbiomul cutanat și cel intestinal. Mai mult, studiile au demonstrat că antibioterapia afectează atât microbiomul intestinal cât și pe cel cutanat, conducând astfel la disbioză. Acest lucru se datorează faptului că antibioticele nu distrug numai bacteriile responsabile pentru infecția în cauză. După încheierea tratamentului antibiotic, microbiomul se reface, dar nu revine niciodată la normal.
Având în vedere impactul pe care microbiomul îl are asupra sănătății, în literatură se discută despre modificarea acestuia în scop terapeutic. Acest lucru se poate realiza utilizând probi-

otice. Acestea sunt microorganisme vii benefice organismului uman. Administrate topic, pot regla microflora cutanată, iar administrate oral, interacționează cu microflora intestinală.
Probioticele modulează sistemul imun prin stimularea diferențierii celulelor
T reglatorii și a producerii de citokine antiinflamatorii. Printre cele mai mult studiate familie de probiotice, se regăsesc Bifidobacterium și Lactobcillus, acestea având rol antipruritic, respectiv rol de refacere a barierei cutanate.
Din nefericire, deși există numeroase studii care au analizat posibilul rol al probioticelor în tratamentul dermatitei, acestea nu au arătat dovezi clare care să susțină utilitatea administrării probioticelor. Deși câteva studii au sugerat o îmbunătățire a scorului SCORAD și a calității vieții în urma administrării de probiotice, totuși datele actuale sunt considerate neconcludente.
Cu toate că în literatură există date contradictorii cu privire la rolul administrării probioticelor la pacienții cu dermatită atopică, acestea pot fi luate în considerare ca posibile strategii alternative de tratament sau ca tratamente adjuvante, alături de tratamentele topice/sistemice conforme ghidurilor actuale.
1 Mazur M, Tomczak H, Łodyga M, Plagens-Rotman K, Merks P, Czarnecka-Operacz M. The Intestinal and Skin Microbiome in Patients with Atopic Dermatitis and Their Influence on the Course of the Disease: A Literature Review. Healthcare [Internet]. 2023 Mar 1 [cited 2023 Jun 10];11(5). Available from: /pmc/articles/PMC10001192/
2 Lee MJ, Kang MJ, Lee SY, Lee E, Kim K, Won S, et al. Perturbations of gut microbiome genes in infants with atopic dermatitis according to feeding type. J Allergy Clin Immunol [Internet]. 2018 Apr 1 [cited 2023 Jun 10];141(4):1310–9. Available from: https://pubmed. ncbi.nlm.nih.gov/29339259/
3 Prebiotics and probiotics for treatment of allergic disease - UpToDate [Internet]. [cited 2023 Jun 10]. Available from: www.uptodate.com/contents/prebiotics-and-probiotics-for-treatment-of-allergic-disease?search=atopic%20dermatitis%20gut%20microbiome&source=search_result&selectedTitle=3~150&usage_type=default&display_rank=3#H5938517
4 Watanabe S, Narisawa Y, Arase S, Okamatsu H, Ikenaga T, Tajiri Y, et al. Differences in fecal microflora between patients with atopic dermatitis and healthy control subjects. Journal of Allergy and Clinical Immunology [Internet]. 2003 Mar 1 [cited 2023 Jun 10];111(3):587–91. Available from: https://pubmed.ncbi.nlm.nih.gov/12642841/
5 Jernberg C, Löfmark S, Edlund C, Jansson JK. Longterm ecological impacts of antibiotic administration on the human intestinal microbiota. ISME J [Internet]. 2007 [cited 2023 Jun 10];1(1):56–66. Available from: https://pubmed.ncbi.nlm.nih.gov/18043614/
6 Fujimura KE, Sitarik AR, Havstad S, Lin DL, Levan S, Fadrosh D, et al. Neonatal gut microbiota associates with childhood multisensitized atopy and T cell differentiation. Nat Med [Internet]. 2016 Oct 1 [cited 2023 Jun 10];22(10):1187–91. Available from: https://pubmed.ncbi.nlm.nih.gov/27618652/












www.ralucaharnagea.ro
Tel: +40.746.935.554
Locatie centrală (lângă Piața Victoriei)
Bld. Ion Mihalache 26-28, parter, sector 1, București
Oferă următoarele servicii
Dermatologie medicală
Dermatologie estetică





Dermatologie chirurgicală
Epilare laser
Laser fracțional CO2
Estetică facială și corporală
Chirurgie estetică
cipale de agenți care pot fi utilizați: antioxidanții și substanțele cu rol în reglarea celulară.
Antioxidanții, cum ar fi vitaminele, polifenolii și flavonoidele, reduc degradarea colagenului prin reducerea concentrației de fracții reactive în țesuturi.
Reglatorii celulari, cum ar fi retinoizii, peptidele și factorii de creștere (GF), au efecte directe asupra metabolismului colagenului și influențează producția acestuia.
Vitaminele C, B3 și E sunt cei mai importanți antioxidanți datorită capacității lor de a pătrunde în piele (au greutatea lor moleculară mică). Acidul L-ascorbic topic (vitamina C) în concentrații între 5 și 15 % s-a dovedit a avea un efect anti-îmbătrânire a pielii prin inducerea producției de colagen de tip I și III și inhibarea matrixmetaloproteinazei. Studiile clinice au dovedit că efectul antioxidant este mai mare combinând vitamina C cu vitamina E decât numai cu vitamina C sau E singure.
Niacinamida (vitamina B3) reglează metabolismul și regenerarea celulelor și este utilizată de obicei în concentrații de 5% pentru rolul său anti-aging.
Vitamina E (α-tocoferol) are efecte inflamatorii și antiproliferative în concentrații între 2% și 20%. Acționează prin netezirea pielii și creșterea capacității stratului cornos de a-și menține umiditatea, de a accelera epitelizarea și de a contribui la fotoprotecția pielii.
Reglatorii celulari, precum derivații de vitamina A, polipetidele și substanțele botanice, acționează direct asupra metabolismului colagenului și stimulează producția de colagen și fibre elastice.
Vitamina A (retinol) și derivații săi (retinaldehida și tretinoina) sunt un grup de agenți cu efect antioxidant. Ele pot induce biosinteza colagenului și pot reduce expresia MMP 1 (metaloproteinaza 1 numită și colagenază 1).
Retinolul este, în prezent, substanța folosită cel mai des în scop anti-aging provocând mai puține reacții adverse (iritații, descuamare, eritem) față de retinoizi mai potenți.
Tretinoina este un retinoid nearomatic de prima generație, este aprobat pentru aplicare ca tratament anti-îm-
bătrânire și se găsește în concentrații între 0.02% și 0.1%. S-a demonstrat că poate reduce semnele îmbătrânirii timpurii a pielii induse de UV, cum ar fi ridurile, pierderea elasticității pielii și pigmentarea.
Polipeptidele sau oligopeptidele sunt compuse din aminoacizi și pot imita o secvență peptidică de molecule precum colagenul sau elastina. Prin aplicarea topică, polipeptidele au capacitatea de a stimula sinteza colagenului și de a activa metabolismul dermal.
• Abordarea unui stil de viață sănătos este esențială în prevenția îmbătrânirii cutanate.
Corelația dintre dietă şi sănătatea pielii a devenit un subiect larg dezbătut în ultimii ani. Un mecanism important dovedit a fi implicat în această legătură este reprezentat de produşii finali de glicație avansată (AGE), care au capacitatea de a-şi exercita efectele negative ce induc modificări ale colagenului cutanat, elastinei şi fibronectinei. Alimentele sunt sursă de zaharuri, care sunt implicate în producerea de AGE dar, în plus, unele alimente conțin AGE preformate.
Antioxidanții nutriționali acționează prin diferite mecanisme și în diferite compartimente, dar sunt în principal captatori ai radicalilor liberi.
Cea mai importantă sursă de antioxidanți este furnizată de dietă, cei mai cunoscuți antioxidanți sistemici fiind vitamina C, vitamina E, carotenoizii și
dintre oligoelemente cuprul și seleniul. Când dieta este precară din varii motive, o sursă la îndemână o reprezintă administrarea de nutricosmetice, suplimente cu rolul de a îmbunătăți din interior către exterior aspectul pielii.
Fumatul este asociat cu apariția ridurilor, asociere de tip doză-efect, dovedindu-se că acesta are o contribuție mai mare la apariția ridurilor faciale decât expunerea la soare. Fumul de tutun conține aproximativ 3800 de constituenți, iar efectele negative asupra pielii sunt rezultatul atât acțiunii directe a componentelor sale asupra epidermei, cât și acțiunilor indirecte (prin circulația sangvină) asupra dermului.
Un exemplu concret al acțiunii fumului de țigară asupra epidermei este nivelul scăzut de umiditate observat în stratul cornos al pielii tenului, urmat de apariția ridurilor faciale. Noțiunea de „somn de calitate” este de fapt foarte importantă, deoarece persoanele private de somn sunt percepute ca fiind mai obosite, mai puțin atractive și chiar mai puțin sănătoase decât atunci când sunt odihnite.
Privarea de somn este asociată cu semne crescute ale îmbătrânirii intrinseci a pielii (riduri fine, pigmentare neuniformă, elasticitate redusă), cu rate de refacere mai lentă a barierei cutanate în cazul unei lezări.
Stressul cotidian are un impact major asupra sănătății, dar și a îmbătânirii premature a pielii. Nivelurile crescute de cortizol (rezultat din stresul cronic) sunt asociate cu modificări importante ale matricei extracelulare, respectiv suprimarea sintazei de acid hialuronic și reducerea masei de colagen. În concluzie, stresul psihologic contribuie la disfuncția imunitară și la deteriorarea ADN-ului ceea ce duce la îmbătrânirea pielii.
Amintim pe scurt cele mai utilizate proceduri minim invazive în scop antiaging: peelingurile chimice superficiale, medii și profunde, terapiile de tip laser non-ablativ, injectările cu acid hialuronic sau cu biostimulatori ai sintezei de colagen (hidroxiapatita de calciu, acidul polilactic și policaprolactona), terapia vampir( injectare de plasmă proprie bogată în trombocite), injectare de toxină botulinică pentru a relaxa ridurile de expresie și a prevni apariția altora noi (prin blocarea mușchilor mimicii), proceduri de microneedling, radiofrecvență, HIFU(High Intensity Focused Ultrasound) etc.
Abstract: Drug rash with eosinophilia and systemic symptoms (DRESS) is a severe, idiosyncratic, drug hypersensitivity reaction characterized by an extensive skin exanthema in association with a wide range of mild-to-severe systemic presentations, lymphadenopathy, and eosinophilia. This syndrome causes a diverse array of clinical symptoms, which appear after a prolonged latency period, anywhere from 2 to 8 weeks after initiating the offending drug. Despite the cessation of the offending drug, flares may still continue to occur, a situation which has a worse prognosis. Standardized criteria for the diagnosis have been developed, however, their accuracy is not yet fully cemented. Regrettably, DRESS syndrome is a potentially life-threatening condition for which the therapeutical approach is not yet well supported by strong evidence-based data, and more research is needed in order to provide caretakers with a foolproof protocol, thus early diagnosis is the only reliable key to therapeutical success.
Medic rezident
Dermatovenerologie, Sp. Univ. de
Șef Lucrări Dr. Florica Șandru

Medic primar, Sp. Univ. de Urgență Elias, UMF „Carol Davila”, București
Medic rezident
Dermatovenerologie,


Deși reacțiile de hipersensibilitate cutanată la medicamente sunt probabil cele mai frecvente reacții adverse medicamentoase, afectând aproximativ 7% din populație, ele reprezintă o provocare diagnostică și terapeutică pentru medici și pacienți deopotrivă.
Pielea este organul cel mai frecvent vizat de reacţiile de hipersensibilitate la medicamente, la nivelul acesteia manifestându-se un spectru larg de tipuri de leziuni, fiecare cu morfologie, cronologie și mecanisme de declanșare diferite. Diferite tipuri de reacții întrunesc nu doar caracteristici clinice clasice, ci au și elemente unice entității cauzatoare, astfel încât diagnosticul de certitudine al tipului de reacție de hipersensibilitate devine și mai eluziv, iar o clasificare corectă a acestora este esențială managementului corect. Una dintre cele mai de temut reacții de hipersensibilitate postmedicamentoasă este așa numitul Sindrom DRESS (Reacție postmedicamentoasă cu eozinofilie și simptome sistemice), care constă, precum spune și numele, într-o erupție cutanată heterogenă, extinsă, ce asociază afectare viscerală, eozinofilie cu limfocitoză atipică și limfadenopatii.
În aprox. 80% din cazurile de DRESS s-au putut identifica cu acuratețe un trigger medicamentos, însă în
restul cazurilor relația de cauzalitate nu a putut fi dovedită, iar în 2% din cazuri expunerea la medicamente a fost chiar absentă. Printre medicamentele identificate ca fiind declanșatoare, cel mai frecvent s-au regăsit substanțele antiepileptice aromatice, alopurinolul, sulfonamidele, anumite antibioticele precum vancomicina și minociclina, dar și medicamentele antituberculoase. Există dovezi indirecte că riscul DRESS pentru anumite medicamente este dependent de doză, lucru dovedit și prin efectul aditiv al insuficienței renale la predispoziția genetică pentru sindromul DRESS și de alte reacții adverse cutanate severe induse de alopurinol. În mod similar, clearance-ul plasmatic neadecvat al medicamnetului cu acumularea sa în organism a fost descoperit în multiple cazuri de DRESS și sindrom Stevens-Johnson/Necroliză epidermică toxică (SJS/TEN) indus de fenitoină și minociclină.
Cu toate că sdr. DRESS reprezintă între 10-20% din toate reacțiile ad-
verse cutanate postemedicamentoase, patogeneza sa exactă rămâne neclară. Se crede că aceasta implică o interacțiune complexă între susceptibilitatea genetică și un răspuns imun inadecvat declanșat de medicamente. De asemenea, poate exista o posibilă interacțiune virus-medicament ce culminează cu reactivarea virală. Reactivarea virusurilor din familia Herpesviridae (HHV-6, HHV-7, virusul Epstein-Barr [EBV], citomegalovirusul [CMV]) este un fenomen recunoscut ca fiind asociat cu DRESS și apare la până la 75% dintre pacienți.
Sindromul DRESS este un sindrom complex, caracterizat de o plajă largă de forme clinice. Este important de menționat că debutul reacției efective este întârziat, astfel încât putem descrie o fază de latență, de la inițierea medicamentului până la debutul reacției, ce variază de obicei între două și opt săptămâni, în special dacă medicamentul implicat este un antiepileptic. Perioada de latență poate fi însă mult mai scurtă, în special în cazurile provocate de antibiotice beta-lactamice. Această faza prodromală a DRESS este adesea caracterizată de simptome nespecifice, cum ar fi febra, fatigabilitata și limfadenopatiile.
Manifestările cutanate sunt cele mai evidente și sunt adesea primul indiciu diagnostic. Erupția începe ca o erupție maculopapulară eritematoasă, cu diverse grade de confluare, cu debut rapid, progresiv, și cu remanență de aproximativ 15 zile (90% din cazuri). De asemenea, pacienții pot prezenta leziuni în țintă, pustule, purpură, plăci infiltrative sau chiar dermatită exfoliativă. Leziunile sunt distribuite simetric pe trunchi și extremități, 80% dintre pacienți având implicat > 50% din suprafeța corporale (BSA). Angioedemul facial este izbitor și prezent în majoritatea cazurilor (70%). Pruritul nu este un simptom predominant, la fel ca și afectarea mucoaselor poate fi observată doar în până la 50% din cazuri și este, de regulă, ușoară, spre deosebire de cea din sindromul Stevens-Johnson/necroliza epidermică toxică (SJS/ NET).
Simptomele sistemice asociate cu DRESS includ: febră ≥38,5°C (75- 90%), limfadenopatie (54 -65%) și cele generate de implicarea viscerală care apare în 90% din cazuri. Amploarea și tipul leziunii de organ variază, majoritatea pacienților prezentând afectarea unui singur organ intern (90%), însă aprox. 20% dintre pacienți pot avea chiar mai mult de două organe implicate. Afectarea organelor interne poate preceda dezvoltarea erupției cutanate, iar evoluția clinică a manifestărilor cutanate poate să nu fie paralelă cu cea sistemică.
Cea mai frecventă manifestare viscerală a DRESS, care apare în 53 până la 90% din cazuri este injuria hepatică. Majoritatea anomaliilor profilului funcțional hepatic sunt tranzitorii şi în uşoare, ele incluzând modificări de colestază (37%), hepatocitoliză (19%) sau mixte (27%). Cu toate acestea, până la 50% din cazuri pot avea creşteri ale enzimelor hepatice de peste 10 ori limita superioară a normalului, iar deşi insuficiența hepatică acută este rară, ea poate necesita transplant de ficat.
Spectrul de leziuni renale asociate cu DRESS variază de la proteinurie la insuficiență renală acută severă, care apare însă doar la aproximativ 8% din cazuri. Factorii de risc pentru dezvoltarea leziunilor renale în cadrul sindromului includ vârsta înaintată, bolile renale sau cardiovasculare preexistente, dar și identificarea alopurinolului ca factor declanșator al episodului actual.
Afectarea pulmonară este în general ușoară, ea fiind prezentă la aprox. 30% dintre pacienții cu DRESS. Manifestările clinice includ dispnee și tuse uscată, dar complicațiile respiratorii pot include pneumonia interstițială acută, pneumonia interstițială limfocitară, pleurita și sindromul de detresă respiratorie acută.
Implicarea cardiacă este o complicație mai rară, însă severă, ea reprezentând un factor de prognostic negativ.
Afectarea cardiacă poate fi clasificată în miocardită de hipersensibilitate, cu un prognostic mai bun și miocardită eozinofilică, care asociază o mortalitate de peste 50%.
Implicarea sistemului nervos central și periferic, inclusiv paralizia Bell, neuropatia periferică, și vasculita centrală a fost raportată în 2-8% din cazurile DRESS. Afectarea gastrointestinală este mai puțin frecventă, la fel ca și miozita, disfuncția tiroidiană și uveita.
Datorită perioadei de latență extinse și a astfel a prezentării pacientului la medic doar în momentul apariției semnelor și simptomelor caracteristice sindomului DRESS, anameza devine un proces laborios în care examinatorul trebuie să acorde atenție sporită tuturor evenimentelor posibil declanșatoare din ultimele aprox. 8 săptămâni. În acest sens, este de un mare ajutor aplicarea ghidului EEACI (European Academy of Allergy & Clinical Immunology) pentru diagnosticarea și managementul reacțiilor de hipersensibilitate la medicamente, care furnizează un chestionar exhaustiv cu privire la complexul de semne și simptome identificate și istoricul medical și mai ales medicamentos al pacientului.
Cele mai importante elemente paraclinice sunt oferite de hemoleucogramă, care descrie eozinofilia (8295%), leucocitoza (95%), neutrofilia (78%) și uneori limfocitoză (25 -52%). De asemenea, frotiu de sange periferic decelează prezența celulelor mononcleare cu morfologie atipică și predominanța componentei eozinofilice.
La persoanele suspecte de sindrom DRESS, este încurajată efectuarea unei biopsii cutanate, deși trăsăturile cutanate ale sindromului DRESS sunt heterogene și non-specifice. Cele mai întâlnite tipare histopatologice constau în: dermatita de interfață (75%) (un termen histopatologic ce cuprinde complexul de reacții inflamatorii cutanate caracterizate de atacarea epidermului bazal de către limfocitele T, astfel generând vacuolizarea stratului

bazal epidermal); dermatită spongiotică (40-75%); elemente de afectare a peretelui vascular cu celule endoteliale tumefiate, inconjurate de infiltrat limfocitar perivascular și hematii extravazate (50%); infiltrarea dermului cu eozinofile (20-70%); infiltrarea dermului cu neutrofile (40%); limfocitele pot avea trăsături atipice în aprox. 30% din cazuri.
În funcție de forma de boală și afectarea sistemică coexistentă se pot efectua investigații suplimentare precum ecografie abdominală, CT abdominal sau pulmonar, radiografie toracică, sau chiar biopsii hepatice, renale sau cardiace.
Cele mai utilizate criterii pentru confirmarea sau excluderea diagnosticului de DRESS sunt cele incluse în RegiSCAR (Registry of Severe Cutaneous Adverse Reactions) bazat pe principalele manifestări clinice ale DRESS. Conform acestor criterii, un diagnostic de sindrom DRESS necesită prezența a cel puțin trei dintre următoarele: (1) erupție cutanată, (2) febră >38°C, (3) implicarea a cel puțin unui organ intern, (4) anomalii hematologice și (5) excluderea altor cauze posibile.
Evoluția clinică a DRESS este variabilă, neexisând markeri de încredere la prezentare pentru a prezice rezultatul. De regulă, odată cu sistarea medicamentului trigger, erupția cutanată și implicarea viscerală se rezolvă treptat. Timpul mediu de recuperare este de aproximativ șapte săptămâni, dar până la 20% dintre pacienți pot avea o evoluție mai prelungită care durează chiar mai mult de 90 de zile. Cu toate acestea, reactivarea virală și, în special, reactivarea citomegalovirusului (CMV), detectată în cursul bolii, este asociată cu un prognostic mai slab. DRESS sever a fost definit în mod arbitrar ca cazurile de DRESS cu implicare severă a organelor, care pun viața în pericol și care au ca rezultat internarea la unitatea de terapie intensivă (ICU) sau decesul, rata de mortalitate a sindromului fiind estimată între 2-10%. La supraviețuitorii DRESS au fost observate diverse sechele autoimune care includ tiroidita autoimună, vitiligo, alopecia areata, anemia hemolitică autoimună, LES și diabetul de tip 1, astfel este imperativ necesar ca pacientii să fie monitorizați pe termen lung. Recăderile pot exista după rezolvarea episodului inițial, ele aparând în general în urmatoarele 4-5 luni de la rezoluție. În cele mai multe astfel de cazuri de flare-ups, manifestările sunt de natură cutanată, dar eozinofilia sau creșterea enzimelor hepatice pot apărea, precum și reactivarea concomitentă a HHV6. Flare-up-urile tind să fie mai frecvente la pacienții tratați cu corticosteroizi sistemici la care reducerea dozei a fost efectuată mai rapid. De asemenea, recidivele pot fi declanșate și de medicamente care pot fi structural diferite de medicamentul cauzal inițial. Motivul reactivității încrucișate prezentă frecvent de pacienții cu DRESS este incomplet elucidat, dar se crede că aceasta rezultă dintr-o hiperactivare imună declanșată de episodul inițial de DRESS care duce la polisensibilizare la mai multe medicamente. Astfel expunerea de rutină și empirică la antibiotice sau alte medicamente este descurajată atât pe perioada episodului acut cât și ulterior remiterii sale.
Gestionarea sindromului DRESS implică sistarea imediată a administrării medicamentului declanșator și terapie suportivă. Corticosteroizii sistemici sunt principalul tratament utilizat și sunt de obicei administrați în doze mari, durata terapiei variind în funcție de severitatea bolii și de răspunsul individual al pacientului. În cazurile de afectare severă a organelor, pot fi luate în considerare terapii suplimentare, cum ar fi imunoglobulina intravenoasă (IVIG) sau plasmafereza. Utilizarea agenților antivirali, cum ar fi aciclovirul, a fost, de asemenea, explorată în unele cazuri pentru a viza reactivarea virală. Pacienții trebuie monitorizați îndeaproape, în cazurile severe chiar într-un cadru de terapie intensivă, din cauza potențialului de deteriorare rapidă.
Având in vedere pleiomorfismul manifestărilor clinice și multitudinea de implicații sistemice ale sindromului DRESS, putem concluziona că diagnosticul precoce al acestuia este elementul central al bunei practici medicale, chiar daca drumul către a pune cu certitudine acest diagnostic și de a identifica factorul declanșator poate fi anevoios.
Bibliografie:
1. Choudhary S, McLeod M, Torchia D, Romanelli P. Drug Reaction with Eosinophilia and Systemic Symptoms (DRESS) Syndrome. J Clin Aesthet Dermatol. 2013;6(6):31-37.
2. Brockow K, Ardern-Jones MR, Mockenhaupt M, et al. EAACI position paper on how to classify cutaneous manifestations of drug hypersensitivity. Allergy. 2019;74(1):14-27. doi:10.1111/ all.13562
3. Haur Yueh Lee MRCP, Drug reaction with eosinophilia and systemic symptoms (DRESS) 2023, Uptodate
4. Sasidharanpillai S, Ajithkumar K, Jishna P, et al. RegiSCAR DRESS (Drug Reaction with Eosinophilia and Systemic Symptoms) Validation Scoring System and Japanese Consensus Group Criteria for Atypical Drug-Induced Hypersensitivity Syndrome (DiHS): A Comparative Analysis. Indian Dermatol Online J. 2022;13(1):40-45. Published 2022 Jan 24. doi:10.4103/idoj.idoj_196_21
Stratacel este conceput pentru o vindecare mai rapidă și o reducere semnificativă a timpului de recuperare.
Stratacel este cu 50% mai eficient în reducerea timpului de recuperare, cu rezultate vizibile începând cu ziua 2.1
ro.stratacel.com
Stratamed este conceput pentru o vindecare mai rapidă și pentru prevenirea precoce a cicatricilor anormale.
Stratamed ajută rănile să se vindece mai repede și ajută la prevenirea infecțiilor.3,4
ro.stratamed.com
Strataderm este un gel profesional de terapie a cicatricilor pentru prevenirea și tratarea formării anormale și excesive a acestora.


Strataderm este cel mai de încredere gel de terapie a cicatricilor din Australia.6
ro.strataderm.com



Stratamark este dovedit clinic pentru prevenirea și tratamentul vergeturilor. 8,9
Stratamark poate fi utilizat și în combinație cu alte tratamente pentru vergeturi, inclusiv terapia cu laser, doar cu recomandare medicală.
ro.stratamark.net

Resurfacing laser corectiv - Faţă2




Dr. Marini, SDC The Skin Doctors Center, Trieste, Italy

pansament inovator pentru proceduri fractionale
Chirurgie MOHS5 - Buza superioară



Monoterapie cu Stratamed
Cicatrice hipertrofică liniară după excizia chirurgicală a unui nev7 - Torace
Vârsta cicatricilor înainte de tratament: 14 luni Cicatricea din stânga a rămas netratată, cicatricea din dreapta a fost tratată timp de 2 luni.
pansament avansat tip film pentru plagi
Stratamark a fost aplicat de la naștere, până la 6 luni post-partum.8 Pacientul avea atât antecedente personale, cât și familiale de vergeturi.
gel pentru terapia cicatricilor
pentru prevenirea si tratamentul vergeturilor
Atenție: Citiți întotdeauna prospectul, utilizați numai conform instrucțiunilor. Numai pentru uz extern. Nu trebuie aplicat peste alte tratamente pentru piele fără sfatul medicului dumneavoastră. Dacă apare iritația, întrerupeți utilizarea și consultați medicul dumneavoastră. Poate păta hainele dacă nu este complet uscat. În cazul în care apar pete, curățarea chimică ar trebui să fie capabilă să le îndepărteze fără a deteriora țesătura. Pentru o depozitare corectă, vă rugăm să închideți tubul bine cu capacul. A nu se lăsa la îndemâna copiilor. Nu utilizați după data de expirare (EXP) imprimată pe tub. Data de expirare (EXP) nu se modifică odată ce tubul a fost deschis. A se evita contactul cu ochii. Nu este adecvat pentru plăgi umede, foarte exsudative, răni tunelizate sau arsuri de gradul 3. În cazul în care rana dumneavoastră prezintă semne de infecție sau nu se vindecă după 30 de zile, consultați medicul dumneavoastră. Nu necesită metode speciale de eliminare. Vă rugăm să respectați reglementările locale de eliminare la deşeuri a materialelor de ambalare. Referințe: 1. Gold, M., et al. (2019). J of Cosmetic Dermatology, 18(2), pp. 524-529. 2. Prin amabilitatea lui Leonardo Marini, MD - SDC The Skin Doctors Center Trieste, Italia, 2017. 3. Lucattelli, E., et al. (2021). Annals of Burns and Fire Disasters, 34(1), pp. 53-57. 4. Sandhofer, M., Schauer, P. (2012). SKINmed, 10, S1-S7. 5. Prezentat în cadrul Societății Internaționale de Chirurgie Dermatologică (ISDS) 2015 (primăvară) de Dr. Benedetto, Cartagena (Columbia). 6. Date Iqvia MAT Nov 2021. 7. Date la dosar, 2010 (Studiul Dr. A. Irwin). Stratpharma AG. 8. Malkova, S. (2014). Noua revistă de medicină a UE, 1-4/4, pp. 1-7. 9. Hughes, CD, Hedges, A. (2018). Australasian Journal of Dermatology, 60(1), pp. 78-80.
Fabricat de: Stratpharma AG, Aeschenvorstadt 57, CH-4051 Basel, Elveția

Distribuit în România: Meditrina Pharmaceuticals SRL, Intrarea Măguricea Nouă, nr. 7-7A, Sector 1, Bucuresti,
 Începerea tratamentului cu Stratamed După 2 luni de tratament cu Stratamed
Începerea tratamentului cu Stratamed După 2 luni de tratament cu Stratamed

Abstract: Considering that melanoma is still the most dangerous skin cancer, the primary goal of this research was the clinical, histological and immunohistochemical evaluation of an uncommon case of de novo melanoma. The dermoscopy displayed the asymmetry, polymorphism and polychromatism of the neoplasm; the histological analysis revealed a microscopic structure similar to an epithelioid cell melanoma, with inflammatory reaction and central ulcerations. The immunohistochemical exam with melanocytic differentiation markers exposed the presence of pagetoid-disseminated tumor cells into the epidermis, as well as deep dermis invasion and the development of tumor cells throughout the hair follicles. This atypical case exhibited surprising characteristics, such as emerging on healthy skin, the gradual evolution, the infrequent age and phototype III of the patient and the rare exposure to ultraviolet radiations. Consequently, the immunohistochemical markers played a crucial role in the differential diagnosis.
Melanomul malign cutanat (MMC) continuă să reprezinte o chestiune de actualitate în patologia dermatologică, întrucât pune probleme deosebit de dificile de diagnostic, evoluție și, mai ales, de tratament[1,2]. Atâta vreme cât, la ora actuală, nicio schemă terapeutică[3], nicio combinație de chimioterapice și/sau imunomodulatoare[4], utilizate singure sau în asociere cu alte metode fizioterapice sau chirurgicale, nu asigură vindecarea, MMC va rămâne în continuare subiectul princeps al cercetărilor din domeniul oncologiei[5,6].

Cazul pe care îl prezentăm îl considerăm pe cât de interesant, pe atât de instructiv, datorită, pe deoparte, modului de debut „de novo“, pe tegument aparent sănătos, la o vârstă de peste 50 de ani, iar, pe de altă parte, pe un teritoriu cutanat neexpus decât ocazional la raze UV.
Cazul de față implică un pacient, M.H., 54 de ani, din mediul urban, care a fost internat în Clinica de Dermatologie a Spitalului Clinic Județean de Urgență Craiova, pentru prezența unei formațiuni


tumorale cu diametrul de 1cm, pigmentată, localizată la nivelul omoplatului drept.
Din afirmațiile pacientului, tumora a apărut în urmă cu aproximativ 2 ani, a crescut lent în dimensiuni și și-a modificat forma și culoarea în timp.
Dintre factorii de risc, am reținut că pacientul era un mare fumător (peste un pachet de țigări pe zi) și supraponderal cu un indice IMC de 26,8. Fototipul în care se încadra pacientul era III. Antecedentele personale patologice au arătat o hipertensiune arterială gradul II.
La examenul obiectiv, s-au constatat tegumente de culoare normală, cu o foliculită a coapselor și ganglionii limfatici superficiali nepalpabili. Local, la nivelul omoplatului drept, s-a observat o formațiune tumorală cu margini neregulate, de culoare brun-negricioasă, cu polimorfism cromatic, ușor reliefată de la planul tegumentului (3-4 mm), cu diametrul de aproximativ 1cm. Marginile tumorii erau ușor infiltrate, iar suprafața boselată nu era dureroasă spontan sau la palpare.
Aspectul clinic al tumorii, polimorfismul cromatic, suprafața boselată, marginile neregulate, sunt indicii care au sugerat melanomul malign în timpul procesului de diagnostic diferențial.
Examenul dermatoscopic s-a efectuat cu un dermatoscop FotoFinder care a arătat o leziune asimetrică cu polimorfism și policromatism, cu rețea pigmentară atipică și prezența „vălului“ care caracterizează melanomul malign (Figurile 1-4).
S-a decis intervenția chirurgicală, excizându-se tumora „in toto“, cu zonă de siguranță oncologică și sutură „per-primam“, iar piesa s-a trimis la Laboratorul de Anatomie Patologică pentru examenul histopatologic.
Fragmentul tisular excizat a fost fixat în formol tamponat 10% și a fost prelucrat prin tehnica histopatologică clasică de includere la parafină. Din blocurile de parafină au fost efectuate secţiuni de 3-4 microni care au fost colorate iniţial cu coloraţia uzuală Hematoxilină-Eozină (HE). Ulterior, au fost efectuate secţiuni seriate, care au fost etalate pe lame tratate cu poli-L-lizină în vederea examenului imunohistochimic.
Tehnica imunohistochimică utilizată a fost tehnica în doi pași cu straptavidină-biotină ca anticorp secundar (kit LSAB plus, DakoCytomation, Danemarca), iar cromogenul utilizat pentru vizualizarea imunoreacţiei a fost AEC (3-amino-9-etillcarbazol). Anticorpii primari utilizaţi au fost sugeraţi de aspectul microscopic observat pe coloraţia uzuală și au fost reprezentaţi de: Proteina S100 (policlonal, DakoCytomation, diluţie 1:500), HMB45 (clona HMB45, DakoCytomation, diluţie 1:50), Tirozinaza (clona T311, Novocastra, diluţie1:40) și Ki-67 (clona MIB1, DakoCytomation, diluţie 1:100).
Examenul histopatologic a confirmat suspiciunea clinică, evidențiind o structură microscopică de melanom malign, intens pigmentat, cu celule epitelioide, ulcerat central și cu o reacție inflamatorie moderată. Indicele Clark a fost III, iar indicele Breslow sub 1mm (663 microni). (Figurile 5-8).
Examenul imunohistochimic, efectuat cu ajutorul markerilor de diferențiere melanocitară, a arătat un marcaj nuclear și citoplasmatic intens și difuz al proteinei S100 în celulele tumorale. Imunomarcajul HMB45, Tirozinazei și Melan A a fost citoplasmatic intens în celulele de
la nivelul limitei dermice a tumorii, fără descreșterea expresiei acestor markeri odată cu creșterea profunzimii, iar paternul imunoexpresiei a fost de tip patchy. Acești markeri au evidențiat prezența celulelor tumorale diseminate pagetoid în epiderm și extensia celulelor tumorale în și în jurul foliculilor piloși. Expresia nucleară a markerului de proliferare celulară Ki-67 a avut un nivel redus, sugerând o activitate proliferativă redusă în celulele tumorale.
Melanomul malign este cea mai agresivă tumoră cutanată de origine melanocitară, cu evoluție rapidă și cu mare capacitate de metastazare[7,8]. Literatura de specialitate clasică și articolele rezultate din cercetări moderne subliniază că MMC este o tumoră care se dezvoltă, de regulă, pe un nev preexistent, dar poate lua naștere și pe un tegument aparent normal[9,10]
Incidenţa crescută în ultimele decade se datorează expunerii mai intense la radiaţii ultraviolete tip B (UV-B)[11,12] și reprezintă 1-3% din totalul tumorilor maligne și 7-8% din cele cutanate[13,14]. În ciuda progreselor terapeutice realizate, prognosticul pacienţilor cu MMC rămâne nefavorabil, iar datele statistice recente arată că media de supravieţuire variază între 6-8 luni, supravieţuirea la 5 ani fiind mai mică de 5%, cu sublinierea că MMC metastatic rămâne incurabil[15,16]
Managementul terapeutic al acestor pacienți s-a îmbunătățit permanent, dar nicio asociere de chimioterapice și/sau imunomodulatoare sau alte metode moderne fizioterapice sau chirurgicale nu au asigurat o vindecare de durată[17,18,19].
Cazul prezentat de noi, cu un indice de prognostic Clark III și Breslow de 663 microni, la care s-a intervenit târziu pentru excizia tumorii, ridică aceleași incertitudini privind stabilirea schemei terapeutice. Acesta necesită a fi discutat pentru faptul că pacientul a dezvoltat un MMC „de novo“ pe tegumente aparent indemne (fără nicio modificare prealabilă), expuse doar ocazional la soare, la vârsta când această patologie apare destul de rar. Evoluția lentă, care a depășit 2 ani, este neobișnuită pentru MMC[20,21]
Imunomarcajul cu markerii de difererențiere melanocitară: proteina S100,
HMB45, Tirozinaza și Melan A, a evidențiat prezența celulelor tumorale diseminate pagetoid în epiderm, profunzimea tumorii la nivel dermic și extensia celulelor tumorale în și în jurul foliculilor piloși.
Expresia HMB45 a arătat absența maturării celulelor din profunzimea leziunii, astfel expresia acestui marker nu a descrescut odată cu creșterea adâncimii în derm. Dimpotrivă, celulele tumorale din profunzimea leziunii au exprimat intens acest marker, cu un pattern de tip patchy (Figura 9). O imunoexpresie similară s-a observat și în cazul Tirozinazei și a lui Melan A, acest aspect susținând lipsa de maturare a celulelor tumorale de la nivelul profund al leziunii. (Figurile 10,13)
Numeroase studii au demonstrat rolul antigenilor de difererențiere melanocitară (proteina S100, HMB45, Tirozinaza și Melan A) în distincția dintre melanoamele maligne și nevii melanocitari comuni sau displazici[22,23]. HMB45 este în mod special util în detectarea pattern-ului de maturare al nevilor, descreșterea expresiei acestui marker odată creșterea în profunzimea dermului sau expresia difuză pe toată suprafața leziunii fiind sugestive unui diagnostic benign, precum un nev. În contrast cu nevii, melanoamele cutanate primare exprimă, de obicei, HMB45 într-un pattern de tip patchy, cu celule izolate sau împrăștiate în toată suprafața dermului. Expresia Tirozinazei este foarte similară cu cea a lui HMB45[22].
Markerul de proliferare celulară Ki67 a fost exprimat la un nivel redus în celulele melanocitare dermice, comparativ cu keratinocitele proliferative din straturile bazale ale epidermului (Figurile 11, 12). Acest aspect ar fi putut pune sub semnul întrebării diagnosticul de melanom malign, dar absența maturării celulelor tumorale din prufunzimea leziunii a orientat spre un melanom malign. Activitatea prioliferativă redusă evidențiată cu Ki-67 în cazul studiat, pe de o parte se corelează cu evoluția lentă pe care a avut-o leziunea și pe de altă parte sugerează o agresivitate redusă și evoluție favorabilă în continuare.
O expresie crescută a lui Ki-67 în melanoamele cutanate primare, corelată atât cu indicele Breslow, cât și cu prezența ulcerației, a fost raportată și de alte cer-

cetări[24, 25]. Totuși, nu s-a demonstrat nicio legătură semnificativă cu prognosticul pacienților. Cu toate că alte studii imunohistochimice au arătat o corelație între expresia lui Ki-67 și prognosticul pacienților cu melanom[26], acestea luau în considerare tumori cu o grosime mai mare[27]. În studiul lui Witold Kycler din 2006, antigenul Ki-67 a fost detectat în zona nucleară a celulelor tumorale de melanom primar, în 70% din cazuri și s-a demonstrat o corelație statistică cu probabilitatea de supraviețuire sau deces. Este foarte probabil ca nivelul expresiei lui Ki-67 să se dovedească a fi util în determinarea agresivității și a potentialului metastatic al melanoamelor[28]
• În majoritatea cazurilor, melanomul malign se dezvoltă pe un nev preexistent, dar poate lua naștere și „de novo“, în general la persoanele tinere, evoluția sa fiind rapidă. Cei mai predispuși sunt indivizii care se încadrează în fototipul I sau II, iar factorul de risc cel mai important în dezvoltarea tumorii este expunerea excesivă la radiații ultraviolete.
• Importanța acestui caz constă în faptul că tumora a prezentat niște particularități neobișnuite: s-a format pe tegument sănătos, a evoluat lent, pacientul avea vârsta de peste 50 de ani, se încadra în fototipul III, iar teritoriul cutanat pe care a apărut leziunea fusese expus rareori la radiații ultraviolete. Coroborând toate aceste date, cazul s-a dovedit interesant și demn de luat în calcul de către literatura de specialitate.
• Datele clinico-statistice publicate, precum și experiența clinică acumulată, scot în evidență necesitatea stabilirii unor reguli de monitorizare pentru perioade mai lungi și a unei categorii mai largi de populație cu risc crescut (purtători de nevi displazici, sporadici sau familiali, persoane cu profesii ce presupun expunerea îndelungată la raze UV naturale sau artificiale, indivizi cu fototip I sau antecedente personale/familiale de MMC etc.).
• Imunomarcajul cu markeri ai diferențierii melanocitare este important în diagnosticul diferențial al nevilor melanocitari displazici de melanoamele maligne cutanate, în timp ce imunomarcajul cu markerul de proliferare
celulară Ki-67 este foarte util în determinarea agresivității și a potențialului metastatic al melanoamelor maligne cutanate dezvoltate „de novo“.
• Tendința tinerilor din societatea de astăzi, de a exagera cu orice preț expunerea la raze UV este extrem de riscantă și impune un anumit nivel de educație sanitară privind vestimentația adecvată, precum și utilizarea rațională și eficientă a protecției solare cu produse „ecran“.
• Din datele de mai sus rezultă că MMC continuă să reprezinte o preocupare importantă pentru cercetarea biologică și clinică și, atâta vreme cât nu există un tratament considerat standard real, cazurile cu metastaze ar trebui incluse în studii clinice sistematice.
1. Robin LH, Wittekind C. UICC/AJCC – Cancerele pielii. In: TNM - clasificarea tumorilor maligne. 6th ed, Editura Ministerului Sănătăţii, 2005, 123-130.
2. Liu ZJ, Herlyn M. Melanoma. In: DeVita VT, Hellman S, Rosenberg SA (ed). Cancer: principles and practice of oncology. 7th ed, Lippincott, Williams & Wilkins, Philadelphia, 2005, 1745-1824.
3. Eggermont AM. Adjuvant therapy in malignant melanoma: an update based on randomized trials. 17th International Congress on Anti-Cancer Treatment Abstract Book, Paris, 2006, 40-43.
4. Kirkwood JM, Ibrahim JG, Sondak VK, et al. High- and low-dose interferon alfa-2b in high-risk melanoma: first analysis of Intergroup trial E1690/S9111/C9190. J Clin Oncol, 2000, 18(12):2444-2458.
5. Wagner WR, Casciato DA. Skin cancers. In: Casciato DA (ed). Manual of clinical oncology. 5th ed, Lippincott, Williams & Wilkins, Philadelphia, 2004, 355-358.
6. Wagner JD, Gordon MS, Chuang TY, et al. Current therapy of cutaneous melanoma. Plast Reconstr Surg, 2000, 105(5):1774-1799.
7. Albertini MR, Longley J, Harary PM, et al. Cutaneous melanoma. In: Chang AE, Ganz PA, Hayes DF (ed). Oncology - an evidence based approach. Springer, New York, 2006, 1073-1092.
8. Burmeister BH, Smithers BM, Poulsen MG. Skin and melanoma cancer. In: Pollock RE (ed). UICC Manual of oncology. 9th ed, Wiley & Sons, New York, 2003, 325-340.
9. Hegge PU, Gause B. Skin cancers and melanoma. In: Abraham J, Allegra CJ, Gulley J (ed). Bethesda handbook of clinical oncology. 2nd ed, Lippincott, Williams & Wilkins, Philadelphia, 2005, 283-307.
10. Wagner WR Jr, Casciato DA. Skin cancers. In Casciato DA (ed). Manual of clinical oncology. 5th ed, Lippincott, Williams & Wilkins, Philadelphia, 2005, 355-368.
11. Manola J, Atkins M, Ibrahim J, et al. Prognostic factors in metastatic melanoma: a pooled analysis of Eastern Cooperative Oncology Group trials. J Clin Oncol, 2000, 18(22):3782-3793.
12. Tsao H, Cosimi AB, Sober AJ. Ultra-late recurrence
(15 years or longer) of cutaneous melanoma. Cancer, 2001, 79(12):2361-2370.
13. Eggermont AMM, Keiholty U, et al. What is the role of biological response modifiers in the treatment of melanoma? In: Newton Bishop JA, Gore M (ed). Melanoma: critical debates. Blackwell Science, Oxford, 2002, 195-211.
14. Payene A. Skin cancers. In: Cassidy J, Bissett D, Obe AJS (ed). Oxford Handbook of oncology. 2nd ed, Oxford University Press, Oxford, 2010, 460.
15. Sabel SM, Sondak VK. Malignant melanoma: current state of primary and adjuvant treatment. Cancer Future, 2004, 3:76-82.
16. Ollila DW, Hsueh EC, Stern SL, et al. Metastasectomy for recurrent stage IV melanoma. J Surg Oncol, 2002, 71(4):209-213.
17. Jensen EH, Margolin KA, Sondak VK. Melanoma and other skin cancers. In: Pazdur R, Coia LR, Hoskins WJ (ed). Cancer management: a multidisciplinary approach. 10th ed, CMP Medica Oncology, New York, 2007, 523-554.
18. Jost LM, Jelic S, Purkalne G. ESMO minimum clinical recommendations for diagnosis, treatment and follow-up of cutaneous malignant melanoma. Ann Oncol, 2005, 16(1):i66-i68.
19. Terando A, Sabel MS, Sondak VK. Melanoma: adjuvant therapy and other treatment options. Curr Treat Opt Oncol, 2003, 4(3):187-199.
20. Jost L. Cutaneous malignant melanoma: ESMO Minimum clinical recommendations for diagnosis, treatment and follow-up. Ann Oncol, 2007, 18(2):ii71-ii73.
21. Rădulescu D., Stolnicu S., Dimitriu S. Consideratii clinico-morfologice în melanoamele maligne cutanate. Jurnalul de Chirurgie, 2006, 2(4):359-369.
22. Prieto VG, Shea CR, Reed JA: Anathema or useful? Application of immunohistochemistry to the diagnosis of melanocytic lesions. In: Shea CR, Reed JA and Prieto VG (ed). Pathology of Challenging Melanocytic Neoplasms:diagnosis and management, Springer, New York, 2015, 34-48.
23. Lohmann CM, Iversen K, Jungbluth AA, et al. Expression of melnocyte differentiation and ki-67 in nodal nevi and comparison of ki-67 expression with metastatic melanoma. Am J Surg Pathol, 2002, 26(10):1351-1357.
24. Hazan C, Melzer K, Panageas AS, et al. Evaluation of the proliferation marker MIB-1 in the prognosis of cutaneous malignant melanoma. Cancer, 2002, 95:634-640.
25. Henrique R, Azevedo R, et al. Prognostic value of Ki67 expression in localized cutaneous malignant melanoma. J Am Acad Dermatol, 2003, 43(6):991-1000.
26. Ostmeier H, Fuchs B, Otto F, et al. Prognostic immunohistochemical markers of primary human melanomas. Br J Dermatol, 2001, 145:203-209.
27. Straume O, Sviland L, Arkslen LA. Loss of nuclear p16 protein expression correlates with increased tumor cell proliferation (Ki-67) and poor prognosis in patients with vertical growth phase melanoma. Clin Cancer Res, 2000, 6:1845-1853.
28. Kycler W, Grodecka-Gazdecka S, Bręborowicz J, Filas V, Teresiak M. Prognostic factors in melanoma. Rep Pract Oncol Radiother, 2006, 11(1): 39-48.


Misiunea DermLite este să creeze instrumente de cea mai înaltă calitate și simplu de folosit pentru dermatoscopie.
Compania, fondată în anul 1999 în California, este recunoscută pentru design-ul de produs de ultimă generație cu performanțe înalte













Produsele DermLite sunt construite manual de către cei mai pricepuți tehnicieni din sudul Californiei.
Designul produselor DermLite ușurează activitățile de zi cu zi ale utilizatorilor

Acest lucru permite acestora să se concentreze pe ce este cu adevărat important: pacientul

Pentru un tratament simplu, rapid și eficient împotriva verucilor, leziunilor comune ale pielii și leziunilor speciale ale mucoasei.
este o alternativă HYDROZID® portabilă și convenabilă la azotul lichid, cu eficacitate dovedită în tratarea verucilor, condiloamelor, keratozei seboreice, keratozei actinice și a altor leziuni benigne, pre-maligne și speciale ale mucoasei.

este utilizat în HYDROZID®


întreaga lume de către medicii generaliști, pediatri, dermatologi, podologi, urologi și ginecologi.
Avantaje:
Fără anestezice
Fără echipament de protecție Fără pregătire înainte de utilizare
Aplicații: Crochordon Keratoza actinica (non-facială sau facială)
Sângerare de contact cervical Condilom acuminat Hiperpigmentarea gingivală Keratoza seboreică
Lentigo (non-facial sau facial) Molluscum contagiosum


Scleroderma represents a rare disease affecting the skin and the connective tissue. It encompasses a series of pathophysiological changes, the main cause being a local inflammatory reaction with consequent excessive production of fibrin, resulting in an extensive fibrotic process and ultimately atrophy. It can easily be classified into 2 main cathegories such as localized scleroderma (juvenile localized scleroderma -JLS- due to the frequency in the pediatric population) and systemic scleroderma - much more present in the adult life. With the main subject of this article being juvenile localized scleroderma, it is necessary to further analyse and divide it into its 4 clinical forms which are: liniar, circumscribed, pansclerotic and mixed. The mean age of presentation is between 7-17 years and the most common form of JLS is the liniar one. Clinically, liniar scleroderma apprears as a fibrotic lesion following a liniar band , transverse if present on the trunk and longitudinal on the limbs, with a hyperemic border and an ivory center during the active phase, while during the inactive phase the lesion may be either hypo- or hyper-pigmented. Regarding the laboratory tests and paraclinical results, the hemoleukogram findings are non-specific and can show isolated eosinophilia with normal biochemical analysis. An useful approach which quantifies the severity of the illness is represented by dosing the autoantibodies which are antinuclear antibodies (ANA) in a high percentage of patients, followed by anti-histone antibodies (AHA) and anti-single-stranded DNA antibodies (ssDNAAb). Rheumatoid factor is frequently detected in generalized morphea, also correlating to the presence of arthritis. Differential diagnosis can be made with systemic scleroderma, lipodystrophy, scleromyxedema and post-radiation morphea. Directions of treatment are as follows: physiotherapy, lanolin-based emollients for single circumscribed lesions, methotrexate used in association with systemic glucocorticoids or as a bridge therapy during the first 2-3 months of therapy with methotrexate. There are also experimental therapies studied, such as biologic agents (tocilizumab, abatacept). Regarding the progression of the disease, there are several clinical assessments such as the score LoSCAT (Localized Scleroderma Cutaneous Assessmnet Tool), computerized scoring, infrared termography to detect the active lesions and high-frequency ultrasound. In conclusion, JLS is a multifaceted pathology with a high risk for disabling morbidity for the child. It is usually difficult to diagnose and there must be raised awareness between clinicians, in order to obtain a clear diagnosis and an adapted therapeutic approach.
Sclerodermia reunește un grup de boli cărora le aparţine ca trăsătură comună prezenţa unui proces inflamator, cu producerea unui mecanism de fibroză extinsă, aflându-se cu predilecţie la nivelul dermului și al ţesutului subcutanat, uneori acompaniat și de anomalii la nivel visceral. În clasificarea grosieră a patologiei se diferenţiază o entitate denumită sclerodermie localizată, cunoscută și sub numele de morfee, cu o prevalenţă de peste 95% în populaţia pediatrică și, o a doua entitate, cu implicare multisistemică: sclerodermie sistemică (de 6- 10 ori mai puţin întâlnită în populaţia pediatrică și aparţinând în literatura clasică sindromului CREST- acronim pentru: Calcinoză, Sindrom Raynaud, Dismotilitate esofagiană, Sclerodactilie, Teleangiectazii).
Sclerodermia juvenilă localizată (morfeea), se separă în 3 entităţi majore:
1. Forma liniară- cea mai frecventă formă în populaţia pediatrică, unde leziunea fibrotică prezintă un traiect liniar, cu orientare predominant transversă atunci când localizarea este la nivelul trunchiului, sau longitudinală atunci când localizarea este la nivelul membrelor. În faza activă se observă o leziune cu un contur roșiatic, hiperemic, în timp ce centrul este decolorat. În faza inactivă leziunea poate fi hipopigmentată sau hiperpigmentată. Pacienţii pot dezvolta contracturi musculare la acest nivel. Leziunea localizată la nivelul feţei se denumește „en coupe de sabre”.

2. Forma circumscrisă - caracterizată printr-o zonă circumscrisă indurată, rotundovalară, de culoare asemănătoare fildeșului, delimitată de un contur violaceu.
3. Forma profundă (pansclerotică) - cea mai puţin comună formă, dar cea mai debilitantă, ce implică ţesutul adipos subcutanat.
4. Forma mixtă - o combinaţie între două sau mai multe dintre entităţile anterioare. Etiologia sclerodermiei nu este cunoscută cu exactitate. Există însă un consens cu privire la mecanismul etiopatogenic, compus din suita: vasculopatie, mecanism
autoimun, reacţie inflamatorie locală marcată cu predominanţa celulelor T helper de tip 1 si 17 si a IFN- gamma, urmată de stimularea exagerată a fibroblaștilor - rezultând în fibroză iar ulterior atrofie. Factorii declanșatori includ infecţiile, traumatismul local, posibilitatea existenţei unei reacţii grefă contra gazdă (împotriva unor celule materne persistente- microchimerism), lezarea celulelor endoteliale rezultând în creșterea expresiei moleculelor de adeziune. S-a demonstrat că moleculele de adeziune au capacitatea de a fixa trombocitele și celulele inflamatorii, provocând manifestări precum Fenomenul Raynaud.
Diagnostic clinic:
Principala modalitate de diagnostic este constituită de examenul clinic, furnizând criteriile de clasificare inițiale. În ceea ce privește manifestările clinice, vârsta medie de prezentare a manifestărilor cutanate este între 7-17 ani. Manifestările extracutanate pot fi prezente la peste 20% din populaţia pediatrică, predominant în forma localizată.
Sclerodermia juvenilă localizatăforma liniară: apare sub formă de benzi sclerotice, cu precădere la nivelul membrelor (cu orientare longitudinală), mai
rar la nivelul feţei și la nivelul trunchiului (frecvent transversală).
Implicate în forma cu localizare la nivelul membrelor sunt și manifestări de tipul: atrofie a ţesutului subcutanat, mușchilor, periostului și ocazional și a sinovialei, deformări în varus/ valgus, contracturi în flexie, deformări ale degetelor.
În forma cu localizare la nivelul feţei, supranumită și „en coup de sabre”, care se prezintă iniţial printr-o etapă de inflamaţie acută, cu o leziune albă, indurată, înconjurată de un halou eritematos și ulterior drept o leziune alb- sidefie, fermă, cu consistenţă ceroasă, delimitată de un contur violaceu. Leziunile sunt frecvent limitate la o hemi-faţă, asociindu-se cu alopecie localizată pe zona de traiect. Unele cazuri se pot complica cu anomalii vasculare în teritoriul cerebral, fiind descrise în literatură și deficite vizuale, convulsii, paralizii faciale, distonii și neuropatii.
Manifestările extracutanate sunt caracteristice majoritar formei liniare, fiind constituite de:
• patologie musculo- scheletală: artrită, tenosinovită, contracturi musculare, miozită și atrofie musculară;
• patologie neurologică: cefalee, convulsii, encefalita Rasmussen, neuropatie periferică, simptome neuropsihiatrice. O evaluare prin IRM cerebral poate evidenţia modificări focale și difuze, atrofie cerebrală, calcificări și anomalii vasculare;
• alte boli autoimune;
• patologie gastro-intestinală: boală de reflux gastro-esofagian, disfagie;
Ulterior, o biopsie lezională, incluzând paniculul adipos subcutanat, poate fi utilă în confirmarea patologiei. Pacienții care prezinta sindrom Raynaud precum și autoanticorpi anti-nucleari (ANA) pot fi testaţi pentru Sclerodermia sistemică. Pacienţilor cu leziuni profunde le poate fi utilă o examinare prin IRM care să cuantifice severitatea leziunilor- îngroșarea fasciei musculare, tenosinovită sau sinovită, precum ultrasonografia poate fi utilă pentru monitorizarea leziunilor.
Investigaţii de laborator:
Diagnosticul sclerodermiei juvenile localizate nu este dependent de rezultatele paraclinice. Hemoleucograma poate decela eozinofilie izolată, biochimia și sumarul de urină fiind în general în limite normale. În practica curentă se pot efectua investigaţii mai țintite, care cuantifică severitatea bolii precum - dozarea autoanticorpilor - în prin-
cipal pe cei de tip antinuclear (ANA)- fiind cei mai frecvent asociaţi cu această patologie (testaţi prin imunofluorescenţă indirectă), autoanticorpi anti-histone (AHA) și anti-ADN-monocatenar. Se pot testa și autoanticorpii anti-centromer si anti-topoizomerază, având însă o corelație mai scăzută cu severitatea patologiei. În contrast, autoanticorpii anti-ADN dublu catenar sunt mult mai rar implicaţi în patologie. Factorul reumatoid (FR) este frecvent detectat în sclerodermia juvenilă localizată, forma generalizată, (morfeea generalizată), corelându-se și cu prezenţa artritei. În formele cu implicare musculară, dozarea creatin-fosfokinazei poate decela cantități crescute ale acestei enzime.
Diagnostic diferențial:
Este esențial de diferențiat morfeea de sclerodermia sistemică, datorită implicării multiorganice, precum și a prognosticului rezervat al celei din urmă. Leziunile pot avea aspecte clinice similare altor patologii precum lipodistrofia - boală congenitală caracterizată printr-o pierdere a țesutului subcutanat, scleromixedemul și morfeea post-iradiere.
Tratament:
Managementul terapeutic include măsuri nonfarmacologice precum fizioterapia, menită să ofere un prognostic favorabil privind mobilitatea și menținerea capacității funționale a regiunilor afectate de leziunile fibrotice. În ceea ce privește măsurile farmacologice, se poate determina o abordare terapeutică sugestivă gradului de afectare:
• Pentru leziunile ușoare - precum forma circumscrisă a morfeei - nu se recomandă terapie sistemică, fiind suficientă folosirea unor emolienți pe bază de lanolină, calcipotriol sau topice pe baza de glucocorticoizi cu concentrații scăzute.
• Pentru leziunile moderat-severe se recomandă folosirea metotrexatului, in doze de 0.6-1 mg/kgc/doză/ săptămână (maximum 25 mg/ săptămână), per os sau subcutanat, pentru cel puțin 24 de luniînainte de scăderea progresivă a dozelor (literatura sugerând o eficacitate mai mare atunci când este prelungit mai mult de 2 ani). Poate fi asociat cu glucocorticoizi sistemici de tipul prednisonului - ca adjuvant în doze de 0,5-1 mg/kg/zi în primele 2-3 luni de la începerea metotrexatului, pentru o acțiune mai rapidă. Combinația este recunoscută a aduce ameliorări atunci când este folosită pentru 2-13 luni. Există și studii în cadrul unor terapii ex-
perimentale ce includ tocilizumabul (un anticorp monoclonal direcționat împotriva IL-6 - frecvent implicată în patofiziologia formei localizate a sclerodermiei), cu rezultate promițătoare în populația pediatrică pentru formele liniară și pansclerotică. De asemena, abatacept, o altă direcție terapeutică relevantă pentru utilizarea la populația pediatrică cu fome rezistente la tratamentele de primă linie, cu predilecție în formele liniare cu implicare musculo-scheletală, s-a evidențiat în limitarea gradului de fibroză dermală.
Evaluarea progresiei bolii
S-au constituit scoruri de evaluare a gradului de severitate precum LoSCAT, compus din LoSSI (Localized Scleroderma Severity Index) și LoSDI (Localized Scleroderma Damage Index), care divizează suprafața corpului în 18 regiuni anatomice și cunatifică elemente precum grosimea tegumantară, gradul de inflamație și extensia leziunilor folosind un interval de 0-3 puncte. Este obiectivată și experiența pacientului în raport cu boala printr-un scor de tipul PROMs (Patient-reported outcome measures), menit să surpindă răspunsul subiectiv la terapia inițiată.
Au fost explorate și strategii noninvazive de urmărire a gradului de progresie, printre care s-au evidențiat termografia în infraroșu, ultrasonografia, Doppler- flowmetria (ce măsoară microcirculația subcutanată, detectând cu acuratețe leziunile active), IRM-ul (indicat în leziunile de tip liniar cu localizare cefalică unde se suspectează o posibilă afectare neurologică).
Concluzionând, sclerodermia juvenilă localizată este o patologie rară, multifațetată, cu implicații atât funcționale cât și de ordin estetic, dificil de diagnosticat, ce necesită mobilizarea medicilor pediatrii, dermatologi cât și reumatologi în vederea obținerii unui diagnostic prompt și inițierea unei abordări terapeutice adaptate un prognostic promițător
1. Nelson Textbook of Pediatrics. 21st ed., Philadelphia, Elsevier, 2020.
2. „Juvenile Localized Scleroderma: Is It a Benign Disease?” Revista Colombiana de Reumatología (English Edition), vol. 24, no. 3, July 2017, pp. 129–130, https://doi.org/10.1016/j.rcreue.2017.10.002.
3. Eugen Pascal Ciofu, and Carmen Ciofu. Esentialul in Pediatrie. Bucuresti, Amaltea, 2002.
4. Zulian, MD, Francesco . “Juvenile Localized Scleroderma.” Www.uptodate.com, 11 May 2021, www.uptodate.com/contents/juvenile-localized-scleroderma.


Preţ de referinţă pentru DCI Sulodexide, decontat pe lista B
Coreflux 250 ULS capsule moi și Coreflux 600 ULS/2 ml soluţie inj. (i.v./i.m.) sunt medicamente biologice autorizate pe bază de sulodexide.
Sulodexide este un antitrombotic marcant, activ la nivel arterial și venos cu un profil farmacologic deosebit susținut de efecte pleiotropice: inhibarea aderării plachetare și de activarea sistemului fibrinolitic tisular și circulator.
Sulodexide normalizează parametrii alteraţi ai vâscozităţii sanguine, această acţiune se manifestă în special prin scăderea concentraţiilor plasmatice ale fibrinogenului.
Profilul farmacologic al sulodexidei descris anterior este completat și cu acţiunea de normalizare a concentraţiilor plasmatice crescute ale lipidelor, realizată prin activarea lipoproteinlipazei.
Criteriile* de includere în tratamentul specific pentru Sulodexide/COREFLUX sunt:

• tromboza venoasă profundă (TVP) și în prevenţia recurenţei TVP,
• ameliorarea semnificativă a factorilor de risc pentru afecţiunile vasculare și progresia bolii vasculare, recurenţa unor episoade ischemice fatale și nonfatale,
• tratamentul insuficienţei cronice venoase (IVC) în oricare din stadiile CEAP,
• tratament al unei leziuni ischemice,
• tratamentul bolii ocluzive arteriale periferice (BOAP), și în alte patologii care pot fi considerate ca o consecinţă a unui proces aterosclerotic,

• tratamentul simptomatic al claudicaţiei intermitente, precum și tratamentul durerii de repaus.

• Prevenţia și stoparea complicaţiilor vasculare ale diabetului: nefropatia diabetică, retinopatia diabetică și piciorul diabetic.
• Prin administrarea de Sulodexide poate fi evitată amputarea piciorului diabetic și se poate opri evoluţia retinopatiei și nefropatiei diabetice.
Tratamentul antitrombotic cu Sulodexide/COREFLUX este un tratament de lungă durată, fiind destinat unor afecţiuni cronice și de prevenţie a complicaţiilor diabetului.

Eficacitatea sulodexide, ca medicament biologic, nu depinde de: vârstă, sexul pacientului și nici de severitatea bolii, administrarea fiind benefică pentru toate aceste categorii de pacienţi.
Acţiunea antitrombotică este datorată inhibării, dependente de doză, a unor factori ai coagulării, în principal factorul X activat. Interferenţa cu trombina rămâne însă la un nivel nesemnificativ, coagularea nefiind astfel influenţată.
Astfel, antitromboticul Coreflux pe bază de sulodexide nu prezintă efecte secundare hemoragice, când este administrat oral și are un risc hemoragic redus comparativ cu alţi glicozaminogligani terapeutici (GAGi, ca de ex. heparina și heparina cu greutate moleculară mică) când se administrează pe cale parenterală.

Aceasta este o consecinţă a unei interacţiuni mai reduse cu antitrombina III și a inhibiţiei simultane a cofactorului II al heparinei, obţinându-se o inhibiţie semnificativă a trombinei cu o anti-coagulare sistemică minimă.
Monitorizarea parametrilor sistemici ai hemocoagulării nu este necesară la dozele sugerate. Terapia combinată cu medicamente cu potenţial hemoragice (AINS, antiagregante plachetare etc.) este sigură
Datorită toleranţei deosebite și a procentului foarte redus al efectelor secundare (sub 1%), nu sunt date publicate ce ar recomanda scăderea dozelor, faţă de dozele recomandate uzual.
Inițierea tratamentului se face de către medicii specialiști care diagnostichează și tratează boli vasculare cu risc de tromboză.
Continuarea se face de către medicul de familie în baza scrisorii medicale emise de specialist.

